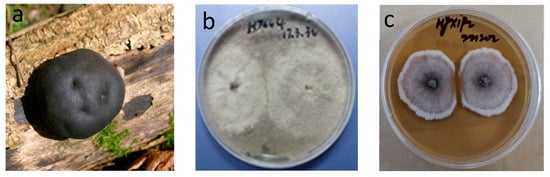

Abstract
The genus Daldinia have long been recognized as a source of structural novel, pharmaceutically relevant natural products. We reviewed the structures and activities of secondary metabolites isolated from the genus of Daldinia from January 1995 to June 2024, and 280 compounds, including six major categories—terpenoids, alkaloids, polyketides, polyphenols, steroids, and other classes—are presented in this review. Among these metabolites, 196 were identified as new structures. Remarkably, 112 compounds exhibited a range of biological activities, including cytotoxic, antimicrobial, anti-inflammatory, antifungal, anti-virus, and enzyme-inhibitory activities. This review highlights the bioactive metabolites discovered in the past three decades from the genus of Daldinia while also exploring the potential of these symbiotic fungi as rich sources of novel and diverse natural products. The varying bioactivities of these metabolites offer a vast array of promising lead compounds and also could significantly contribute to the development of new medicines.
1. Introduction
Endophytes are microorganisms that inhabit diverse organs, tissues or intercellular spaces of plants, animals and other resources, while the hosts generally do not show any symptoms of infection. In general, endophytes include endophytic fungi, endophytic bacteria and endophytic actinomycetes. Endophytes, as a highly significant microbial resource, are prevalent in nature and omnipresent within a diverse range of terrestrial and aquatic plants. Endophytes have been successfully isolated from a diverse range of plants, animals and other resources, including bryophytes, ferns, pteridophytes, hornworts, herbaceous plants, various types of woody plants and some animals [1,2]. Endophytic fungi have gained attention owing to their potential for producing novel bioactive secondary metabolites, with diverse structures and potent activities. The metabolites produced by fungi through various biosynthetic pathways, such as steroids, terpenoids, peptides, alkaloids and polyketides, have shown potent bioactivities, including properties like anticancer, antiviral, antibacterial and antifungal activities, among others [3,4,5]. Thus, endophytic fungi represented a valuable source of novel compounds characterized by structural diversity and pharmacological properties.
Recent advances in fungal genome sequencing and bioinformatics analysis indicate that the secondary metabolite biosynthetic potential of fungi is underappreciated as a greater number of secondary metabolite biosynthetic gene clusters are present in the genome. This is because many of the secondary metabolite gene clusters are silent or lowly expressed under laboratory conditions [6,7]. Accordingly, great efforts have been made to activate the silent/cryptic biosynthetic gene clusters, leading to the discovery of novel secondary metabolites. Therefore, the activation of these silent biosynthetic gene clusters is essential to current natural product discovery research. Several successful strategies have been developed, including chemical epigenetic modification, co-cultivation and the One Strain Many Compounds (OSMACs) approach. These methods are simple and effective for regulating fungal metabolism to activate silent metabolic pathways in the fungus, resulting in the production of cryptic natural products. With the rapid advancement of sequencing technologies, an increasing amount of genomic information pertaining to fungi has been elucidated. Subsequently, molecular biology techniques, such as genome mining, heterologous expression and genome mining in conjunction with the OSMAC approach, were utilized to modulate fungal metabolism [8,9,10,11,12].
As a significant microbial resource, endophytic fungi are widely distributed in nature. Among fungi, the genus Daldinia sp. represented a prevalent endophytic fungus found in both terrestrial and marine environments (Figure 1). The genus Daldinia was described by Cesati and De Notaris (1863) and belongs to Xylariales. Xylariales is one of the largest families in this order, and both the family and the Daldinia genus have been studied exhaustively for secondary metabolite production [13].
Figure 1.
The images of (a–c) of Daldinia spp. (a): Daldinia concentrica; (b,c): Daldinia eschscholtzii.
Therefore, this review updates current compounds to cover metabolites isolated from the fungi genus Daldinia between January 1995 and June 2024. It also provides the structural diversity of the compounds, as well as detailed information on their sources and associated bioactivity. Two hundred and eighty compounds were isolated from the genus Daldinia. Among these isolated compounds, 196 compounds were new compounds. Remarkably, 112 compounds showed various biological activities, such as cytotoxic, antimicrobial, anti-inflammatory, antifungal, antivirus and enzyme-inhibitory activities. Chemical epigenetic modification, co-cultivation, the OSMAC approach and genome mining were employed to activate the silent/cryptic biosynthetic gene clusters within the genus Daldinia, with the aim of obtaining structurally novel and bioactive secondary metabolites. Liquid chromatography–tandem mass spectrometry (LC-MS/MS)-based molecular networking has become a highly efficient strategy for the discovery of new natural products from complex mixtures. The structures and absolute configurations of the new compounds and novel skeleton compounds were elucidated by the analysis of nuclear magnetic resonance (NMR) spectroscopy, MS data, electronic circular dichroism (ECD) calculations and single-crystal X-ray diffraction. This study contributes to a better understanding of the chemical structures and biological activities of secondary metabolites from Daldinia spp., thereby enhancing the process of drug discovery and development.
2. Secondary Metabolites from Daldinia spp. and Their Bioactivities
2.1. Terpenoids
Terpenoids are relatively rare, isolated from the genus Daldinia. Only 21 terpenoids were obtained from the fungi genus Daldinia in the last thirty years. Here, 21 terpenoids, with 16 new terpenoids (including 6 sesquiterpenes, 6 diterpenes and 4 triterpenes), were isolated and identified from the Daldinia spp. (Figure 2).

Figure 2.
Terpenoids produced by Daldinia species (1–21).
Six new sesquiterpenes, methyl-7α-acetoxydeacetylbotryoloate (1), 7α-acetoxydeacetylbotryenedial (2), 7α-hydroxybotryenalol (3), 7,8-dehydronorbotryal (4), 7α-acetoxydehydrobotrydienal (5), 7α-acetoxy-15-methoxy-10-O-methyldeacetyldihydrobotrydial (6), together with four known compounds, 7α-hydroxy-10-O-methyldihydrobotrydial (7), 7-hydroxy-16-O-methyldeacetyldihydrobotrydial-hydrate (8), 7-hydroxydeacetyl-botryenalol (9), and 7α-hydroxydihydrobotrydial (10), were isolated from the fungus Daldinia concentrica (S0318) collected at Laojunshan, Yunnan Province, China [14]. One known compound, rel-(1S,4S,5R,7R,10R)-10-desmethyl-1-methyl-11-eudesmene (11), was isolated from the lichen Punctelia sp. derived fungus Daldinia childiae; the fungus was collected from Cloak Mountain Scenic Area in Guizhou Province of China. Compound 11 exhibited slight α-amylase inhibitory activity at the concentration of 1.5 mg/mL, with an inhibition rate reaching up to 15.99% [15]. Six new 3,4-secolanostane triterpenoids, daldiconoids B–G (12–17), were isolated from the fungus Daldinia concentrica collected from Yunnan Province, China. Compounds 12 and 14–16 inhibited the expressions of IL-1β, IL-6 and TNF-α in lipopolysaccharide-stimulated RAW264.7 cells comparable to the positive control dexamethasone at a concentration of 10 μM. Compound 12 blocked the JAK2/STAT3 signaling pathway induced by lipopolysaccharide [16]. One new triterpenoid, concentricol (18), was isolated from the fungus Daldinia concentrica [17]. Three new triterpenoids, concentricols B–D (19–21), were isolated from the white wax tree trunk-derived fungus Daldinia concentrica (North Rhine Westphalia, Germany) [18] (Figure 2).
2.2. Alkaloids
Alkaloids are an important class of natural products containing a nitrogen heterocycle moiety, which are found in a diverse array of natural sources and exhibit a variety of biological activities. There were 53 alkaloids (including 43 new compounds) isolated and identified from Daldinia spp., including cytochalasins, indole alkaloids, etc. Among them, 21 compounds showed biological activities such as antiviral, antibacterial and cytotoxic properties.
2.2.1. Cytochalasins
Five new cytochalasins, (11)-cytochalasa-6(12), 13,19-triene-1,21-dione-7,18-dihydroxy-16,18-dimethyl-10-phenyl-(7S*,13E,16S*,18S*,19E) (22), (11)-cytochalasa-6(12),13-diene-1,21-dione-7,18-dihydroxy-16,18-dimethyl-10-phenyl-(7S*,13E,16S*,18R*) (23), (11)-cytochalasa-6(12),13-diene-1,21-dione-7,18,19-trihydroxy-16,18-dimethyl-10-phenyl-(7S*,13E,16S*,18S*,19R*) (24), (11)-cytochalasa-6(12),13-diene-1,21-dione-7,18-dihydroxy-16,18-dimethyl-19-methoxy-10-phenyl-(7S*,13E,16S*,18S*,19R*) (25), and (11)-cytochalasa-6(12),13-diene-1,21-dione-7,18-dihydroxy-16,18-dimethyl-19-acetoxy-10-phenyl-(7S*,13E,16S*,18S*,19R*) (26), were isolated from the fungus Daldinia sp. from Quercus acutissima in Tokushima [19]. Eleven new cytochalasins, (11)-cytochalasa-6(12),13,19-triene-l,21-dione-16,18-dimethyl-7-Hydroxy-10-phenyl-(7S*,3E,16S*,18R*,19E) (27), (11)-cytochalasa-6(12),13-diene-1,21-dione-16,18-dimethyl-7-hydroxy-10-phenyl-(7S*,13E,16S*,18S*) (28), (11)-cytochalasa-6(12),13-diene-1,21-dione-7,19-dihydroxy-16,18-dimethyl-10-phenyl-(7S*,13E,16S*,18R*,19R*) (29), (11)-cytochalasa-6,13,19-triene-l,21-dione-18-hydroxy-16,18-dimethyl-10-phenyl-(6Z,13E,16S*,18S*,19E) (30), (11)-cytochalasa-6,13,19-triene-1,21-dione-12,18-dihydroxy-16,18-dimethyl-10-phenyl-(6E,13E,16S*,18S*,19E) (31), (11)-cytochalasa-6,13,19-triene-l,21-dione-17-hydroxy-16,18-dimethyl-10-phenyl(6Z,13E,16S*,17R,18S*,19E) (32), (11)-cytochalasa-13,19-diene-1,21-dione-6,7-epoxy-18-hydroxy-16,18-dimethyl-10-phenyl-(7S*,13E,16S*,18S*,19E) (33), (11)-cytochalas-13-ene-1,21-dione-6,7-epoxy-18,19-dihydroxy-16,18-dimethyl-l0-phenyl-(7S*,13E,16S*,18S*,19R*) (34), (11)-cytochalasa-6(12),13,19-triene-1,17,21-trione-7,18-dihydroxy-16,18-dimethyl-10-phenyl-(7S*,13E,16S*,l8R*,19E) (35), (11)-cytochalasa-5,13-19-triene-1,21-dione-7-hydroperoxy-17-hydroxy-16,18-dimethyl-10-phenyl-(5Z*,7S*,13E, 16S*,17R*,18S*,19E) (36), and 22-oxa-(12)-cytochalasa-6(12),13,19-triene-l,21-dione-7,18-dihydroxy-16,18-dimethyl-10-phenyl-(7S*,13E,16S*,18S*,19E) (37), were isolated from an unidentified fungus Daldinia sp. from the Quercus acutissima in Tokushima [20]. A new cytochalasin, [11]-cytochalasa-6(12),13-diene-1,21-dione-7,19-dihydroxy-16,18-dimethyl-10-phenyl-(7S*,13E,16S*,18R*,19R*) (38), was also isolated from the Quercus acutissima-derived fungus Daldinia vernicosa collected in Tokushima [21]. One new cytochalasin daldinin (39), and two known cytochalasins [11]-cytochalasa-6(12),13-diene-1,21-dione-7,18,19-trihydroxy-16,18-dimethyl-10-phenyl-(7S*,13E,16S*,18S*,19R*) (40), and [11]-cytochalasa-6(12),13-diene-1,21-dione-7,18-dihydroxy-16,18-dimethyl-10-phenyl-(7S*,13E,16S*,18R*) (41), were isolated from the fungus Daldinia concentrica (Pumat National Park of Nghe An Province, Vietnam). Compound 39 showed cytotoxicity against five human tumor cells SK-LU-1, HepG2, Hep3B, SW480 and MCF7, with IC50 values of 11.4 ± 0.5, 13.5 ± 1.3, 13.3 ± 1.4, 13.1 ± 0.9 and 13.5 ± 1.2 µM, respectively. Compounds 40 and 41 showed weak cytotoxicity against all the tested tumor cell lines, with the IC50 values ranging from 23.0 ± 1.1 to 58.2 ± 2.3 µM, respectively [22]. One new cytochalasin, [11]-cytochalasa-5(6),13-diene-1,21-dione-7,18-dihydroxy-16,18-dimethyl-10-phenyl-(7S*,13E,16S*,18R*) (42), was isolated from the mangrove Brguiera sexangula var. rhynchopetala-derived fungus Daldinia eschscholtzii HJ001 (South China Sea, China). Compound 42 exhibited weak antibacterial activity against Escherichia coli, Staphylococcus aureus, Bacillus cereus, Vibrio parahaemolyticus and Vibrio alginolyticus with the same MIC value of 50 μg/mL [23]. One new cytochalasin, 21-(acetyloxy)-6,13,14-trihydroxy-16,18-dimethyl-10-phenyl [11] cytochalasa-7,19-dien-1-one (43), was isolated from the fungus Daldinia concentrica, which was collected from Laojunshan, Yunnan [24]. One known compound, phenochalasin B (44), was isolated from the European ash-derived fungus Daldinia concentrica (North Rhine Westphalia, Germany) [25]. One known compound, cytochalasin O (45), was isolated from a mangrove plant Ceriops tagal-derived fungus Daldinia eschscholzii MCZ-18 (Dong Zhai Gang-Mangrove Garden on Hainan Island, China) [26] (Figure 3).
2.2.2. Indole Alkaloids
Two new skeletally undescribed polyketide–indole hybrid alkaloids, indolpolyketones A (46) and B (47), were isolated from the fungus Daldinia escosholzii from the Tenodera aridifolia gut. Compounds 46 and 47 were isolated and assigned to be constructed through C-N bond formation, which were reported for the first time and were the first example of polyketide–indole hybrids pieced together through C-N bond formation in the 13C-exposed culture of D. eschscholzii. This expands the knowledge about the chemical production of D. eschscholzii through precursor-directed biosynthesis. Therefore, compound 46 was hypothesized to be produced through the Michael addition of DIM with PBEO, which may be catalyzed by an uncertain P450 enzyme. Compound 47 was generated through another round of Michael addition of 46 with 3-methyleneindolium and followed by Wagner–Meerwein rearrangement (Scheme 1). Compounds 46 and 47 showed significant antiviral activity against H1N1 with IC50 values of 45.2 and 31.4 μM, respectively [27]. Two pairs of new skeletally undescribed polyketide–indole hybrids (PIHs) were generated from indole-3-carbinol in the fungus Daldinia eschscholzii from the gut of Tenodera aridifolia. Each indolchromin alkaloid was chirally separated into four isomers, (2S,4R)-indolchromin A (48), (2R,4S)-indolchromin A (49), (2S,4S)-indolchromin A (50), (2R,4R)-indolchromin A (51); and (2S,4R)-indolchromin B (52), (2R,4S)-indolchromin B (53), (2S,4S)-indolchromin B (54), (2R,4R)-indolchromin B (55). Furthermore, the indolchromin construction pathways in fungal culture were clarified through enzyme inhibition, a precursor feeding experiment and energy calculation. The cascade reactions, including decarboxylative Claisen condensation catalyzed by 8-amino-7-oxononanoate synthase (AONS), C(sp3)-H activation, double-bond migration and Michael addition, were compatible during fungal cultivation. Compound 48 was inhibitory against Clostridium perfringens, C. difficile, Veillonella sp., Bacteroides fragilis and S. pyogenes, with MIC values of 2.5, 2.5, 5.0, 6.4 and 2.1 μM, respectively. Compound 49 was inhibitory against C. perfringens, C. difficile, Veillonella sp., Bacteroides fragilis and S. pyogenes, with MIC values of 1.3, 2.5, 5.0, 6.2 and 5.0 μM, respectively. Compound 53 was inhibitory against C. perfringens, C. difficile and S. pyogenes, with MIC values of 6.7, 6.3 and 6.2 μM, respectively. Compounds 49 and 54 showed cytotoxic activity against the human breast cancer cell lines MDA-MB-231 with IC50 values of 27.9 and 131.2 nM, respectively, and 49 was additionally active against human breast cancer cell line MCF-7, with an IC50 value of 94.4 nM [28]. Two new alkaloids, dalesindoloids A (56) and B (57), together with one known compound 3-(1H-indole-3ylmethyl)-2-oxindole (58), were isolated from the gut of Tenodera aridifolia-derived fungus D. eschscholzii. Compounds 56 and 57 exhibited cytotoxic activity against the leukemia HL-60 cell line with IC50 values of 1.0 and 7.4 μM, respectively, and compound 56 also showed antibacterial activity against S. aureus, with an MIC value of 9.1 μM [29]. Two new alkaloids, daldinans B (59) and C (60), were isolated from the fungus Daldinia concentrica collected in Yamanashi Prefecture, Japan [30]. Four new isoindolinone derivatives, daldinans D–G (63–66), together with two known compounds, daldinans A (61) and B (62), were isolated from the stroma of the ascomycete Daldinia concentrica collected at Odaesan National Park in Korea. Compounds 63–66 exhibited potent antioxidant activities with IC50 values of 2.65, 3.40, 3.50 and 3.21 μM, respectively. Compounds 61 and 62 exhibited moderate antioxidant activities, with IC50 values of 12.62 and 39.67 μM, respectively. The structure–activity relationship study indicated that 61 and 64 had a methoxy group at C-7, suggesting the methylation of the carboxyl group in the alkyl side chain enhanced the free radical scavenging activities, and compounds 65 and 66—with a methoxy group at C-5—exhibited similar activity. The methoxy group at C-5 and the methylation of the carboxyl group in the alkyl side chain were crucial to enhancing free-radical scavenging activity [31]. Three known N-alkylated 3-phenyl isoindolinones, entonalactam B (67), daldinan B (62) and daldinan E (64), were isolated from Daldinia sp. Compounds 62, 64 and 67 were synthesized, and the conformational properties of these isoindolinones were examined using their derivatives, revealing the presence of atropisomers (Scheme 2 and Scheme 3) [32]. A pair of new racemic (±) childinins C (68) were isolated from the fungus Daldinia childiae from Kunming Botanical Garden in China [33]. One new alkaloid, daldinin A (69), was isolated from the fungus Daldinia concentrica (Muju county, Jeonbuk province, Korea). Compound 69 exhibited potent 2,2′-azinobis(3-ethylbenzothiazoline-6-sulfonate) radical scavenging activity with an IC50 value of 10.4 μM, which was stronger than the positive control butylated hydroxyanisole (IC50 = 10.8 μM) [34]. One new alkaloid, 1-(3-indolyl)-2R,3-dihydroxypropan-1-one (70), was isolated from the marine-associated fungus Daldinia eschschilzii collected from Scaevola serica branches (Hainan, China) [35] (Figure 4).
2.2.3. Other Alkaloids
One new alkaloid, 3-ethyl-2,5-pyrazinedipropanoic acid (71), along with two known compounds, 2,5-pyrazinedipropanoic acid (72) and cyclo-(Phe-Tyr) (73), were isolated from the marine-associated fungus Daldinia eschschilzii (Hainan, China) [35]. One undescribed alkaloid, daldiconoid A (74), was isolated from the fungus Daldinia concentrica (Yunnan Province, China). Compound 74 was a highly modified 4,6,28,29-tetranorlanostane triterpenoid alkaloid featuring an unusual δ-lactam fused with a flanking cyclopentenone architecture. A plausible biosynthetic pathway for 74 was proposed. The co-isolate 4,22R-dihydroxy-3,4-secolanosta-8,24-dien-7,11-dione-3-oic acid was found in relatively high abundance (0.003%) and was considered the biosynthetic precursor. Dehydration between OH-4 and H-5 in 4,22R-dihydroxy-3,4-secolanosta-8,24-dien-7,11-dione-3-oic acid generated a double bond Δ4, which was subsequently oxidized to a ketone, then the amination, epoxidation, Meinwald rearrangement, oxidized, decarboxylation and nucleophilic addition reactions were used to biosynthesize 74 (Scheme 4). Compound 74 inhibited the expressions of IL-1β, IL-6 and TNF-α in lipopolysaccharide-stimulated RAW264.7 cells at a concentration of 10 μM. Mechanistically, 74 blocked the JAK2/STAT3 signaling pathway induced by lipopolysaccharide [16] (Figure 5).

Figure 3.
Cytochalasins produced by Daldinia species (22–45).

Figure 4.
Indole alkaloids produced by Daldinia species (46–70).

Scheme 1.
The putative biosynthetic pathways of 46 and 47 [27].

Scheme 2.
Synthesis of 62 and 64 [32].

Scheme 3.
Synthesis of 67 [32].

Figure 5.
Other alkaloids produced by Daldinia species (71–74).

Scheme 4.
Putative biogenetic pathway for 74 [16].
2.3. Polyketides
Polyketides are one of the most diverse natural product categories. Here, 125 polyketides were isolated and identified from the fungi genus Daldinia, including 85 new compounds, and 54 compounds exhibited biological activities such as cytotoxicity, antioxidant, insect resistance activity and antibacterial properties.
2.3.1. Xanthones
Three new compounds, daldipyrenones A–C (75–77), were isolated from the lichen Myelochroa aurulenta-derived fungus Daldinia pyrenaica 047188 (Korea). Compound 75 exhibited significant antimelanogenic activity with an EC50 value of 3.36 μM, better than positive controls arbutin (54.49 μM) and hydroquinone (4.66 μM), and showed moderate adiponectin-secretion promoting activity. Daldipyrenones are likely derived by combining a chromane biosynthesis intermediate, 1-(2,6-dihydroxyphenyl)but-2-en-2-one, and a spiro-azaphilone, pestafolide A, via a radical coupling or Michael addition to form a bicyclo[2.2.2]octane ring. Genome sequencing of the strain revealed two separate biosynthetic gene clusters responsible for forming two biosynthetic intermediates, suggesting a proposed biosynthetic pathway (Scheme 5) [36]. Two new compounds, daldiniaeschsones A (78) and B (79), were isolated from the Cinnamomum bejolghota-derived fungus Daldinia eschscholtzii SDBRCMUNKC745 (Chiang Mai, Thailand). The putative biosynthetic pathway of compounds 78 and 79 are shown in Scheme 6. Compounds 78 and 79 showed potent α-glucosidase inhibitory activity, with IC50 values of 0.16 and 0.23 mM, respectively [37] (Figure 6).

Scheme 5.
Putative biosynthetic pathway of compounds 75–77 [36].

Scheme 6.
Putative biosynthetic pathway of compounds 78–79 [37].

Figure 6.
Xanthones produced by Daldinia species (75–79).
2.3.2. Chromones
One new polyketide, nodulisporin G (80), was isolated from the Tenodera aridifolia-derived fungus Daldinia eschscholzii, the fungus was collected from Purple Mountain in the suburb of Nanjing, China [38]. Two new compounds, 8-O-methylnodulisporin F (81) and nodulisporin H (82), were obtained from the mangrove Brguiera sexangula var. rhynchopetala-derived fungus Daldinia eschscholtzii HJ004 (South China Sea, China). Compounds 81 and 82 showed moderate antibacterial activity against Staphylococcus aureus, methicillin-resistant S. aureus (MRSA) and Bacillus cereus, 81 with MIC values of 6.25, 12.5 and 6.25 µg/mL, respectively, and 82 with MIC values of 12.5, 12.5 and 6.25 µg/mL, respectively [39]. One new compound, daldiniside A (83), was isolated from the Scaevola serica-derived fungus D. eschschilzii (Hainan, China) [35]. One known compound, 7-O-α-D-ribosyl-5-hydroxy-2-propylchromone (84), was isolated from Euphorbia pekinensis-derived fungus Daldinia eschscholtzii J11 (Xishuang Banna Tropical Botanical Garden, Yunnan Province, China) [40]. OSMAC strategy was used to isolate compounds from the Dendrobium officinale-derived fungus Daldinia eschscholzii JC-15 (Yunnan, China). Daldinsin (85), with an unprecedented benzopyran–naphthalene hybrid skeleton, was isolated from red ginseng medium of the fungus Daldinia eschscholzii JC-15, which exhibited acetylcholinesterase inhibitory activity at the concentration of 50 μM with an inhibition rate of 38.8% [41]. One new compound, karimanone (86), and two known compounds, (S)-5-hydroxy-2-methyl-4-chromanone (87) and 5,7-dihydroxy-2-methyl-4-chromanone (88), were isolated from the fungus Daldinia eschscholtzii KJMT FP4.1 (Karimonjawa National Park). Compounds 87 and 88 were active against a multidrug-resistant strain of Salmonella enterica ser., with MIC values of 125, 62.5 and 125 μg/mL, respectively [42]. One new compound, (R)-5-hydroxy-8-methoxy-2-methylchroman-4-one (89), was isolated from the broad-leaved tree-derived fungus Daldinia eschscholtzii (Deyang City, Sichuan, China) [43]. Three new compounds, 7-hydroxy-5-methoxy-2,3-dimethylchromone (90), 5-methoxy-2-propanone (91), 7-ethyl-8-hydroxy-6-methoxy-2,3-dimethylchromone (92), and three known compounds 2,3-dihydro-5-methoxy-2-methylchromen-4-one (93), 8-methoxy-2-methyl-4H-1-benzopyran-4-one (94), 7-hydroxy-2,5-dimethyl-4H-1-benzopyran-4-one (95), were isolated from mangrove Bruguiera sexangula var. rhynchopetala-derived fungus Daldinia eschscholtzii HJ004 (Hainan, China). Compounds 90 and 93 exhibited α-glucosidase inhibitory activity with IC50 values of 13.0 and 15.0 μM, respectively [44]. Two new compounds, (5R,7R)-5,7-dihydroxy-2-methyl-5,6,7,8-tetrahydro-4H-chromen-4-one (96), (5R,7R)-5,7-dihydroxy-2-copy-5,6,7,8-tetrahydro-4H-chromen-4-one (97), along with two known compounds, (5R,7R)-5,7-dihydroxy-2-methyl-5,6,7,8-tetrahydro-4H-chromen-4-one (98), (5R,7S)-5,7-dihydroxy-2-methyl-5,6,7,8-tetrahydro-4H-chromen-4-one (99), were isolated from lichens-derived fungus Daldinia sp. CPCC 400770 (Laojunshan, Dali Bai Autonomous Region, Yunnan, China). Compounds 96 and 98 exhibited significant anti-influenza A virus (IAV) activities, with IC50 values of 16.1 and 9.0 μM, respectively [45]. One new compound, 8-ethyl-7-hydroxy-5-carboxyl-2,3-dimethylchromone (100), and three known compounds, 5-hydroxy-2-methyl-4H-chromen-4-one (101), 5,8-dihydroxy-2-methylchromone (102) and 5,7-dihydroxy-2-propylchromone (103), were isolated from mangrove B. sexangula var. rhynchopetala-derived fungus Daldinia eschscholtzii HJ004 (South China Sea, China). Compounds 100–103 showed significant antioxidant activity, with IC50 values of 195.03, 20.79, 8.90 and 5.57 μM, respectively, which were stronger than the positive control trolox, with the IC50 value of 292.12 μM [46]. One new compound, 3,5-dihydroxy-2-methyl-4H-chromen-4-one (104), was isolated from the medicinal plant Pogostemon cablin-derived fungus Daldinia eschscholtzii A630 (Yangchun, Guangdong province, China) [47]. One known compound, (2R,4R)-3,4-dihydro-5-methoxy-2-methyl-2H-1-benzopyran-4-ol (105), was isolated from mangrove Pluchea indica-derived fungus Daldinia eschschiltzii KBJYZ-1 (Zhanjiang, Guangdong Province, China) [48]. One known compound, 5-hydroxy-8-methoxy-2-methyl-4H-1-benzopyran-4-one (106), was isolated from the mangrove plant Ceriops tagal-derived fungus Daldinia eschscholzii MCZ-18 (Dong Zhai Gang-Mangrove Garden on Hainan Island, China) [26]. Eight new polyketides, daldinrin A–H (107–114), were isolated from the Colletotrichum sinensis-derived fungus Daldinia eschscholtzii cocultured fermentation products with Colletotrichum pseudomajus (Xishuangbanna of Yunnan Province, China). Compounds 108 and 109, with the unique framework of a benzopyran-C7 polyketone hybrid, and compounds 110–113 were characterized as novel benzopyran dimers. Compound 109 exhibited significant inhibitory activity against the fungi C. pseudomajus and Alternaria sp., with the same MIC value of 1.0 μg/mL, which was stronger than the positive control nystatin. The ether bond at C-4 of the benzopyran derivative increased the antifungal activity [49] (Figure 7).


Figure 7.
Chromones produced by Daldinia species (80–114).
2.3.3. Lactones
One known compound, (+)-mellein (115), was isolated from the medicinal plant Cinnamomum bejolghota-derived fungus Daldinia eschscholtzii SDBRCMUNKC745 (Chiang Mai, Thailand). Compound 115 showed α-glucosidase inhibitory activity with an IC50 value of 0.76 mM [37]. One known compound, (+)-orthosporin (116), was isolated from the terrestrial orchid Paphiopedilum exul-derived fungus Daldinia eschscholtzii (Chiang Mai, Thailand). Compound 116 showed weak activity towards HUVEC cells, with a GI50 value of 90.7 μM, and weak cytotoxicity towards HeLa cells, with a CC50 value of 89.0 μM [50]. One new pyrone daldineschscin B (128), and two known compounds, (3R)-methyl-6,8-dihydroxy-7-methyl-3,4-dihydroisocoumarin (117) and 6-hydroxymellein (118), were isolated from the Euphorbia pekinensis endophytic fungus Daldinia eschscholtzii J11 (Xishuang Banna Tropical Botanical Garden, Yunnan Province, China) [40]. Three known compounds, 2-acetyl-7-methoxybenzofuran (119), 4,8-dimethoxy-1H-isochromen-1-one (120) and (+)-citreoisocoumarin (121), were isolated from Chinese mangrove plant Ceriops tagal-derived fungus Daldinia eschscholzii MCZ-18 (Dong Zhai Gang-Mangrove Garden on Hainan Island, China). Compound 119 showed broad ranges of antimicrobial spectrum against four pathogenic bacteria, Enterococcus faecalis, Methicillin-resistant Staphylococcus aureus, Escherichia coli and Pseudomonas aeruginosa, with MIC values of 12.5, 25, 25 and 12.5 μg/mL, respectively [26]. Two new lactones, daldinisides B (122) and C (123), were isolated from the fungus Daldinia eschschilzii collected from branches of Scaevola serica in Hainan [35]. One new daldiniapyrone, 4-methoxy-5-carboxymethoxy-6-pentyl-2H-pyran-2-one (124), was isolated from the European ash-derived fungus Daldinia concentrica (the state of North Rhine Westphalia, Germany) [25]. Three new compounds, childinins A (125), F (126) and G (127), were isolated from the fungus Daldinia childiae collected from Kunming Botanical Garden. Compounds 125–127 inhibited the growth of S. aureus, S. enterica sub, Pseudomonas aeruginosa at the concentration of 128 μg/mL. Compound 125 showed significant anti-inflammatory activity, with an IC50 value of 21.2 μM, and weak activities against SMMC-7721, MCF-7 and SW480 cell lines [33]. Three new lactones, helicascolides D (129), E (130), and daldinione E (143), and two known metabolites, helicascolides A (131) and B (132), were isolated from mangrove Bruguiera sexangula (Lour.) Poir-derived fungus Daldinia eschscholtzii HJ004 (Hainan, China). Compound 131 had inhibitory activity against α-glucosidase, with an IC50 value of 16 μM [44]. One new compound, helicascolide G (133), was isolated from mangrove B. sexangula var. rhynchopetala-derived fungus Daldinia eschscholtzii HJ004 (South China Sea, China) [46]. One new compound, helicascolide A (134), was isolated from the red algae-derived fungus Daldinia eschscholzii (South Sulawesi Island, Indonesia). Compound 134 showed fungistatic activity at 200 mg/78.5 mm2 spot against plant phytopathogenic fungus Cladosporium cucumerinum [51]. Two new phthalides, daldinolides A (135) and B (136), were isolated from Daldinia concentrica (Yamanashi Prefecture, Japan) [30]. One new benzofuran lactone, concentricolide (137), was isolated from the fungus Daldinia concentrica collected from Lijiang of Yunnan. Compound 137 inhibited HIV-1-induced cytopathic effects, with an EC50 value of 0.31 μg/mL, and exhibited the blockage with the EC50 value of 0.83 µg/mL, on syncytium formation between HIV-1 infected cells and normal cells [52]. Two new compounds, daldinins A (138) and B (139), along with two known compounds isoochracein (140) and 4-hydroxyisoochracein (141), were isolated from fungus Daldinia concentrica (Laojunshan, Yunnan Province, China) [53]. One known compound, curuilignan D (142), was isolated from the European ash-derived fungus Daldinia concentrica (the state of North Rhine Westphalia, Germany) [25]. One new compound, (E)-6-(non-3-en-1-yl)-2H-pyran-2-one (144), was isolated from broad-leaved tree-derived fungus Daldinia eschscholtzii (Deyang City, Sichuan Province, China) [43] (Figure 8).


Figure 8.
Lactones produced by Daldinia species (115–144).
2.3.4. Naphthalenone Derivatives
One new compound, daldinone A (145), was isolated from the European ash-derived fungus Daldinia concentrica (North Rhine Westphalia, Germany) [25]. A new biosynthetically related epoxide-containing daldinone analog, daldinone B (146), and a new chlorinated pentacyclic polyketide daldinone E (147), were purified from the Chrysophyllum cainito-derived fungus Daldinia sp. treated with the epigenetic modifier suberoylanilide hydroxamic acid (SAHA). Compounds 146 and 147 exhibited DPPH radical scavenging activities, with IC50 values of 3.1 and 3.6 μM, respectively, comparable to the positive control ascorbic (IC50 = 3.2 μM) [54]. Two new compounds, daldinones F (148) and G (149), and two known compounds, daldinones C (150) and D (151), were isolated from the orchid Paphiopedilum exul (Ridl.) Rolfe-derived fungus Daldinia eschscholtzii (Chiang Mai, Thailand). Compounds 150 and 151 showed cytotoxic activity towards SW1116 cells, with IC50 values of 41.0 and 49.5 μM, respectively, compared with 37.0 μM for 5-fluorouraci [50]. Two new polyketides, dalmanol C (152) and daldinone F (153), were isolated from Tenodera aridifolia-derived fungus Daldinia eschscholzii (Purple Mountain, Nanjing, China). Compound 152 exhibited moderate cytotoxic activity against human colon adenocarcinoma cell line SW480, with an IC50 value of 9.59 μM [38]. One known compound, 3,4,5-trihydroxy-1-tetralone (154), was isolated from the European ash-derived fungus Daldinia concentrica (the state of North Rhine Westphalia, Germany) [25]. One new polyketide derivative, (1R,4R)-5-methoxy-1,2,3,4-tetrahydronaphthalene-1,4-dio (155), was isolated from mangrove Pluchea indica Less-derived fungus Daldinia eschschiltzii KBJYZ-1 (Zhanjiang, Guangdong Province) [48]. Two known compounds, (+)-regiolone (isosclerone) (156) and (+)-3,4-dihydro-3,4,8-trihydroxy-1(2H)-naphthalenone (157), were isolated from Cinnamomum bejolghota-derived fungus Daldinia eschscholtzii SDBRCMUNKC745 (Chiang Mai, Thailand). Compounds 156 and 157 showed α-glucosidase inhibitory activity, with IC50 values of 0.85 and 0.55 mM, respectively [37]. Two new compounds, daldiniones C–D (158–159), and two known compounds, 4R-(O)-methylsclerone (160) and (−)-cis-(3R*,4S*)-3,4,8-trihydroxy-6,7-dimethyl-3,4-dihydronaphthalen-1(2H)-one (161), were isolated from B. sexangula var. rhynchopetala-derived fungus Daldinia eschscholtzii HJ004 (the South China Sea, China). Compound 161 exhibited α-glucosidase inhibitory activities with IC50 values of 21 μM [44]. One new polyketone, (4R*)-4,8-dihydroxy-3-hydro-5-methoxy-1-naphthhthalenone (162), was isolated from the oak leaves-derived fungus Daldinia sp. (Tokushima) [21]. One known compound, 4,6,8-trihydroxide-3,4-dihydronaphthhalen-1(2H)-one (163), was isolated from the branches of Scaevola sericea Vahl-derived fungus Daldinia eschscholzii (Hainan, China) [35]. One known compound, (-)-regiolone (164), was isolated from the lichen Punctelia sp.-derived fungus Daldinia childiae (Cloak Mountain Scenic Area, Guizhou Province, China) [15]. One new polyketide derivative, (1R,4R)-5-methoxy-1,2,3,4-tetrahydronaphthalene-1,4-dio (165), was isolated from the mangrove Pluchea indica Less-derived fungus Daldinia eschschiltzii KBJYZ-1 (Zhanjiang, Guangdong Province) [48]. One new polyketide, daldinrin K (166), was isolated from the antagonistic coculture with tea phytopathogen Colletotrichum pseudomajus, which induces antifungal cryptic metabolites from isogenesis endophyte Daldinia eschscholtzii against tea phytopathogens. Compound 166 showed anti-feedant activities against silkworms with a feeding deterrence index of 81%. Positive control, abamectin, had antifeedant activity against the silkworms with a feeding deterrence index of 100% at concentrations of 50 μg/cm2 [49]. One new naphthalene derivative, dalesconoside F (167), and four known compounds, nodulisporone (168), xylariol A (169), (4R)-4,8-dihydroxy-3-hydro-5-methoxy-1-naphthalenone (162), (4R)-3,4-dihydro-4,5-dihydroxynaphthalen-1(2H)-one (170), were isolated from mangrove Ceriops tagal-derived fungus Daldinia eschscholzii MCZ-18 (Dong Zhai Gang-Mangrove Garden on Hainan Island, China). Compounds 162 and 170 showed broad ranges of antimicrobial spectrum against five indicator test microorganisms, E. faecalis, Methicillin-resistant S. aureus, E. coli, P. aeruginosa and C. albicans. Compound 162 exhibited antimicrobial activities with MIC values of 25, 12.5, 12.5, 25 and 25 μg/mL, respectively. Compound 170 exhibited antimicrobial activities with MIC values of 50, 25, 50, 25 and 25 μg/mL, respectively [26]. One known compound, nodulone (171), was isolated from the orchid-associated derived fungus Daldinia eschscholtzii (Family Xylariaceae) from the terrestrial orchid Paphiopedilum exul (Ridl.) Rolfe (collected Chiang Mai Thailand) [50] (Figure 9).

Figure 9.
Naphthalenone derivatives produced by Daldinia species (145–171).
2.3.5. Other Polyketides
One new naphthoquinone, daldiquinone (172), was isolated from Daldinia concentrica collected in Yamanashi Prefecture, Japan. Compound 172 exhibited anti-angiogenesis activity against human umbilical vein endothelial cells, with an IC50 value of 7.5 μM [30]. One new polyketide derivative, dalditene A (173), was isolated from the mangrove Pluchea indica Less-derived fungus Daldinia eschschiltzii KBJYZ-1 (Guangdong Province, China). Compound 173 exhibited significant anti-inflammatory activity, inhibiting the expression of iNOS and COX-2 in LPS-induced RAW264.7 cells with an IC50 value of 12.9 μM [48]. One new naphthalene derivative dalesconoside D (174), and a known synthetic analog dalesconoside E (175), were isolated from Chinese mangrove plant C. tagal-derived fungus Daldinia eschscholzii MCZ-18 (Dong Zhai Gang-Mangrove Garden on Hainan Island, China) [26]. Two new compounds, 5-hydroxy-2-methoxy-6,7-dimethyl-1,4-naphthoquinone (176) and 5-hydroxy-2-methoxynaphtho[9–c]furan-1,4-dione (177), were obtained from the mangrove B. sexangula var. Rhynchopetala-derived fungus Daldinia eschscholtzii HJ004 (South China Sea, China). Compound 177 displayed a potent inhibitory activity against α-glucosidase with an IC50 value of 5.7 µg/mL. Compound 176 exhibited antibacterial activity against B. cereus with an MIC value of 12.5 µg/mL [39]. Three new compounds, 3-alkyl-5-methoxy-2-methyl-1,4-benzoquinones,3-heneicosyl (178), 3-docosyl-5-methoxy-2-methyl-1,4-benzoquinone (179) and 5-methoxy-2-methyl-3-tricosyl-1,4-benzoquinone (180), were isolated from the fruiting bodies of Daldinia concentrica (Laojunshan, Yunnan, China) [55]. One new polyketide, daldinrin J (181), was isolated from the antagonistic coculture with tea phytopathogen C. pseudomajus-induced antifungal cryptic metabolites from isogenesis endophyte D. eschscholtzii against tea phytopathogens. Compound 181 exhibited anti-feeding activity against silkworms with a feeding deterrence index (FDI) of 81% at the concentration of 50 μg/cm2 [49]. One known compound, 2-acetyl-7-methoxybenzofuran (182), was obtained from the mangrove B. sexangula var. rhynchopetala-derived fungus Daldinia eschscholtzii HJ004 from the South China Sea. Compound 182 displayed potent inhibitory activity against α-glucosidase with the IC50 value of 1.1 µg/mL [39]. Two new compounds, daldisones A (183) and B (184), were isolated from the fungus Daldinia sp. CPCC 400770. Compounds 183 and 184 exhibited significant anti-influenza virus activity, with IC50 values of 16.0 and 7.4 μM, respectively. Compound 184 showed moderate antibacterial activities against S. aureus, Enterococcus faecalis and B. cereus with MIC values of 32.0, 16.0 and 32.0 μg/mL, respectively [56]. To activate or overproduce secondary metabolites, the native promoter of LaeA-like in Daldinia eschscholzii was substituted by a strong gpdA promoter (amplified from the Aspergillus nidulans genomic DNA), led to the generation of two novel cyclopentenone metabolites, dalestones A (185) and B (186). Compounds 185 and 186 inhibited the expression of TNF-α and IL-6 in LPS-induced RAW264.7 macrophages [57]. One new cyclopentenone, daldineschscin A (187), together with one known compound, xylariphilone (188), were isolated from Euphorbia pekinensis endophytic fungus Daldinia eschscholtzii J11. Compound 188 possessed moderate ABTS+ radical scavenging activity with an IC50 value of 49.13 ± 0.62 μM, compared with the positive control vitamin C, with an IC50 value of 18.27 ± 1.04 μM [40]. One new naphthalene derivative, dalesconoside B (189), and one known compound, fusaraisochromenone (190), were isolated from Chinese mangrove plant C. tagal-derived fungus Daldinia eschscholzii MCZ-18 (Dong Zhai Gang-Mangrove Garden on Hainan Island, China), and compound 189 bore a rare ribofuranoside substituted at C-1 and the 5-methyltetrahydrofuran-2,3-diol moiety. Compound 190 showed antibacterial activity against E. faecalis, Methicillin-resistant S. aureus, E. coli, P. aeruginosa and C. albicans, with MIC values of 12.5, 12.5, 6.25, 12.5 and 25 μg/mL, respectively [26]. One new compound, childinin B (191), was isolated from the fungus Daldinia childiae from Kunming Botanical Garden. Compound 191 showed exhibited remarkable activity against S. aureus with an MIC90 value of 54.9 μg/mL [33]. Two new compounds, daldiniones A–B (192–193), were isolated from the fungus Daldinia eschscholtzii HJ004 from B. sexangula var. Rhynchopetala in Hainan [44]. Two new compounds, eschscholin A (194) and 3-ene-2-methyl-2H-1-benzopyran-5-ol (195), were isolated from the medicinal plant Pogostemon cablin endophytic fungus Daldinia eschscholtzii A630 [47]. Three new compounds, daldionin (196), nodulones B (197) and C (198), were isolated from the orchid-associated fungal strain Daldinia eschscholtzii. The structures of the polyketide metabolites suggest joint biogenetic origins and expand on the known possible reaction channels from the 1,8-dihydroxynaphthalene (DHN) pathway of melanin biosynthesis (Scheme 7). Compound 196 had weak anti-proliferative activity against HUVEC (GI50 98.4 μM) and K-562 cell lines (GI50 85.5 μM) [50]. One known compound, pyranlyketide (199), was isolated from the antagonistic co-culture with tea phytopathogen Colletotrichum pseudomajus induced antifungal cryptic metabolites from isogenesis endophyte Daldinia eschscholtzii [49] (Figure 10).

Scheme 7.
Putative biosynthetic pathway of polyketides (116, 171, 197–198) [50].

Figure 10.
Other polyketides produced by Daldinia species (172–199).
2.4. Polyphenols
2.4.1. Naphthols
Four new compounds, 1,1′,3′,3″-ternaphthalene-5,5′,5″-trimethoxy-4,4′,4″-triol (200), 3,1′,3′,3″-ternaphthalene-5,5′,5″-trimethoxy-4,4′,4″-triol (201), 1,1′,3′,1″-Ternaphthalene-5,5′,5″-trimethoxy-4,4′,4″-triol (202), 3,1′,3′,1″-Ternaphthalene-5,5′,5″-trimethoxy-4,4′,4″-triol (203), and one known compound nodulisporin A (204), were isolated from the lichen Parmelia adaugescens-derived fungus Daldinia childiae 047215 (Mt. Halla, Jeju Island, South Korea). Compounds 201 and 204 exhibited concentration-dependent adiponectin synthesis-promoting activity, with EC50 values of 30.8 and 15.2 μM, respectively, and had bounded to three peroxisome proliferator-activated receptor (PPAR) subtypes (PPARα, PPARγ, and PPARδ). In addition, compound 201 transactivated retinoid X receptor α, whereas 204 did not. Naphthol oligomers 201 and 204 represented novel pan-PPAR modulators and were potential pharmacophores for designing new therapeutic agents against hypoadiponectinemia-associated metabolic diseases [58]. Six new compounds 1,1′,3′,3″,1″,1‴-quaternaphthalene-5,5′,5″,5‴-tetramethoxy-4,4′,4″4‴-tetraol (205), 1,1′,3′,1″,3″,3‴-quaternaphthalene-5,5′,5″,5‴-tetramethoxy-4,4′,4″4‴-tetraol (206), 3,3′,1′,1″,3″,3‴-quaternaphthalene-5,5′,5″,5‴-tetramethoxy-4,4′,4″4‴-tetraol (207), 1,1′,3′,3″,1″,3‴-quaternaphthalene-5,5′,5″,5‴-tetramethoxy-4,4′,4″4‴-tetraol (208), 3,1′,3′,1″,3″,3‴-quaternaphthalene-5,5′,5″,5‴-tetramethoxy-4,4′,4″4‴-tetraol (209), 3,1′,3′,3″,1″,3‴-quaternaphthalene-5,5′,5″,5‴-tetramethoxy-4,4′,4″4‴-tetraol (210), and two known compounds nodulisporins B (211) and E (212), were isolated from lichen Parmelia adaugescens-derived fungus Daldinia childiae 047219 (Hannah Mountain in Jeju Island, South Korea). Feature-based molecular networking analysis suggested six new tetramers (205–210) were composed of the 5-methoxy-4-naphthol skeleton, each of which was connected to one another in various positions. Compound 212 had significant NO inhibitory effects on LPS-induced RAW cells, reducing NO production by more than 50% at the concentration of 25 and 50 μM, respectively [59]. A pair of novel polyphenolic compounds with undescribed seven-ring frameworks of the carbon skeleton, (-)-galewone (213) and (+)-galewone (214), were isolated from mantis Tenodera aridifolia-derived fungus Daldinia eschscholzii IFB-TL01 and proposed a possible pathway for its formation (Scheme 8). Compounds 213 and 214 were observed to reduce the cell viability of activated hepatic stellate cells CFSC-8B with IC50 values of 3.73 ± 0.21 and 10.10 ± 0.41 μM, respectively [60]. A pair of new compounds, (+)-spirodalesol (215) and (-)-spirodalesol (216), were isolated from Daldinia eschscholzii residing in the mantis Tenodera aridifolia gut. Compounds 215 and 216 significantly suppressed the secretion of IL-1β with IC50 values of 0.67 and 0.70 μM, respectively, which indicated approximately 30-fold greater activity than the positive control andrographolide (IC50 = 21.53 μM) [61]. One new compound, selesconol (217), was isolated from Daldinia eschscholzii IFB-TL01 as an inducer for the differentiation of rat bone marrow mesenchymal stem cells into neural cells [62]. Two pairs of new enantiomers, (±)-dalesconols A and B, with an unprecedented carbon skeleton, were isolated from the gut of the mantis species Tenodera aridifolia-derived fungus Daldinia eschscholzii IFB-TL01. Optical resolution of (±)-dalesconol A and (±)-dalesconol B by HPLC on a chiral phase gave the corresponding enantiomers, (+)-dalesconol A (218), (-)-dalesconol A (219) and (+)-dalesconol B (220), (-)-dalesconol B (221) [63]. Two new naphthalene derivatives, dalesconosides A (222) and C (223), were isolated from mangrove plant C. tagal-derived fungus Daldinia eschscholzii MCZ-18 (Dong Zhai Gang-Mangrove Garden on Hainan Island, China). Compound 222 was bearing a rare ribofuranoside substituted at C-1 and the 5-methyltetrahydrofuran-2,3-diol moiety. Compound 222 showed broad ranges of the antimicrobial spectrum against five pathogenic bacteria, E. faecalis, Methicillin-resistant S. aureus, E. coli, P. aeruginosa and C. albicans, with MIC values of 6.25, 25, 12.5, 6.25 and 25 μg/mL, respectively. Compound 223 showed antimicrobial activity against E. faecalis, Methicillin-resistant S. aureus, E. coli and P. aeruginosa with MIC values of 25, 25, 25 and 12.5 μg/mL, respectively [26]. One known compound, 8-methoxynaphthalen-1-ol (224), was isolated from the fungus Daldinia loculata collected from Laojunshan in Yunnan Province [64]. One new compound, daldiniol G (225), was isolated from the medicinal plant Anoectochilus roxburghi endophytic fungus Daldinia sp. TJ403-LS1 (Wuhan, Hubei Province, China). Compound 225 showed good butyrylcholinesterase (BChE) inhibitory activity, with an IC50 value of 15.53 ± 0.39 μM, better than the positive control neostigmine with an IC50 value of 49.60 ± 6.10 μM. Molecular docking was performed to investigate the binding mode of compound 225 to BChE. Three-dimensional models showed that the active compound 225 fitted well in the active pocket of BChE surrounded with Asp70, Trp82, Gly115, Gly116, Glu197, Tyr332, Tyr472 and His438. Further analysis revealed that compound 225 formed hydrogen bonds with Glu197, and their benzene ring structure formed π-π conjugation with Trp82 and cation-π interaction with potassium ion [65]. One known compound, 1,8-dimethoxynaphthalene (226), was isolated from the Euphorbia pekinensis endophytic fungus Daldinia eschscholtzii J11 (Xishuang Banna Tropical Botanical Garden, Yunnan Province, China) [40]. One new naphthofuran, 1,3,8-trimethoxynaphtho[9–c]furan (227), was obtained from mangrove B. sexangula var. Rhynchopetala-derived fungus Daldinia eschscholtzii HJ004 (South China Sea, China) [39]. One known compound, 4:5:4′:5′-tetrahydroxy-1:1′-binaphthyl (228), was isolated from the European ash-derived fungus Daldinia concentrica (the state of North Rhine Westphalia, Germany) [25] (Figure 11).

Scheme 8.
Putative biosynthetic pathway of (±) galewone (213–214) [60].


Figure 11.
Naphthols produced by Daldinia species (200–228).
2.4.2. Phenolics
Five new phenolics, daldiniols A–E (229–232, 235), and two known analogs, 4-hydroxy-3-(3-methylbut-3-en-l-ynyl) benzyl alcohol (233) and 4-methoxy-3-(3-methylcut-3-en-l-ynyl) benzyl alcohol (234), were isolated from medicinal plant Nelumbo nucifera endophytic fungus Daldinia sp. TJ403-LS1. Compound 229 exhibited remarkable immunosuppressive activity against LPS and anti-CD3/anti-CD28 mAbs-activated murine splenocyte proliferation with the same IC50 value of 0.06 μM and BChE inhibitory activity with an IC50 value of 6.93 ± 0.71 μM. Compound 234 showed potent BChE inhibitory activity, with an IC50 value of 16.00 ± 0.30 μM, better than the positive control neostigmine (IC50 = 49.60 ± 6.10 μM). Molecular docking was performed to investigate the binding mode of compounds 229 and 234 to BChE. Three-dimensional models showed that the active compounds 229 and 234 fitted well in the active pocket of BChE surrounded with Asp70, Trp82, Gly115, Gly116, Glu197, Tyr332, Tyr472 and His438. Further analysis revealed that compound 225 formed a hydrogen bond with Glu197, and their benzene ring structure formed π-π conjugation with Trp82 and cation-π interaction with potassium ion. These two compounds could also form π-π conjugate with His438 and form additional hydrogen bonds with Tyr128 and Ser198, respectively [65]. One new polyketide derivative, dalditone B (236), was isolated from the mangrove-derived fungus Daldinia eschschiltzii KBJYZ-1 (Zhanjiang, Guangdong Province, China) [48]. One known compound, orcinotriol (237), was isolated from Scaevola serica-derived fungus Daldinia eschscholzii (Hainan, China) [35]. One known compound, 4-(2-hydroxyethyl) phenol (238), was isolated from the fungus Daldinia loculata, which was collected from Laojunshan in Yunnan Province, China [64]. Three new benzenes daldins, A–C (239–241), along with one known benzene derivative, 2-hydroxymethyl-3-(1-hydroxypropyl) phenol (242), were isolated from fruiting bodies of fungus Daldinia concentrateca S0318 (Laojunshan, Yunnan Province, China) [66]. One new polyketide, daldinrin L (243), was isolated from the co-cultured fermentation products from Colletotrichum pseudomajus and Daldinia eschscholtzii. Compound 243 exhibited anti-feeding activity against silkworms with a feeding deterrence index (FDI) of 70% at the concentration of 50 μg/cm2, while the positive control, abamectin, had anti-feedant activity against the silkworms with the FDI of 100% at the concentration of 50 μg/cm2 [49]. Three known phenolic compounds, stachyline C (244), 3-methoxy-4-hydroxyphenylethanol (245) and 3-hydroxy-4-methoxy-phenylethanol (246), were isolated from lichen-derived fungus Daldinia sp. CPCC 400770 (Laojunshan, Dali Bai Autonomous Region, Yunnan Province, China) [45]. Two new compounds, childinins D (247) and E (248), were isolated from the fungus Daldinia childiae from Kunming Botanical Garden [33]. One known compound, 2-(hydroxymethyl)-3-(1-hydroxypropyl) phenol (249), was isolated from the fungus Daldinia concentrica obtained from Laojunshan in Yunnan Province [53]. One known compound, AB5046A (250), was isolated from the fungus Daldinia eschscholtzii KJMT FP4.1 (Karimonjawa National Park). Compound 250 was active against the multidrug-resistant strain of Salmonella enterica ser. Typhi with an MIC of 125 μg/mL [42]. One new hydronaphthalenone, (3S)-3,8-dihydroxy-6,7-dimethyl-α-tetralone (251), was isolated from the mangrove plant Bruguiera gymnorrhiza (L.) Soavigny endophytic fungus Daldinia eschscholtzii PSU-STD57 (Suratthani province, Thailand) [67]. Three known compounds, 3-hydroxy-1-(2,6-dihydroxyphenyl)butan-1-one (252), 1-(2,6-dihydroxy-phenyl)butan-1-one (253) and 1-(2,6-dihydroxyphenyl) ethan-1-one (254), were isolated from the Euphorbia pekinensis endophytic fungus Daldinia eschscholtzii J11. Compounds 252 and 253 possessed moderate ABTS+ radical scavenging activity with IC50 values of 43.66 ± 1.36 and 28.08 ± 1.03 μM, respectively, compared with the positive control vitamin C, with the IC50 value of 18.27 ± 1.04 μM. Compound 252 showed weak DPPH radical scavenging activity with an IC50 value of 182.27 ± 2.42 μM, compared with vitamin C (IC50 = 12.29 ± 0.43 μM) [40]. Three new compounds, daldispols A–C (255–257), were isolated from the lichen-derived fungus Daldinia sp. (Laojunshan, Dali Bai Autonomous Region, Yunnan Province, China). Compounds 255 and 257 exhibited significant anti-influenza A virus (IAV) activities, with IC50 values of 12.7 and 6.4 μM, respectively [45] (Figure 12).

Figure 12.
Phenolics produced by Daldinia species (229–257).
2.5. Steroids
Steroids are a kind of natural active substance with a wide range of sources. Six steroids were isolated from the genus of Daldinia (Figure 13), including two new compounds, and four compounds exhibited cytotoxicity and anti-inflammatory activity.

Figure 13.
Steroids produced by Daldinia species (258–263).
Two known triterpenoid compounds, ergosterol (258) and ergosterol peroxide (259), were isolated from the fungus Daldinia concentrica collected from a national park in Yee On Province, Vietnam. Compound 258 showed weak cytotoxicity against HepG2, Hep3B and MCF7 cells, with IC50 values of 21.5 ± 5.1, 21.7 ± 2.8 and 43.6 ± 5.1 µM, respectively. Compound 259 showed weak cytotoxicity against HepG2 and Hep3B cells, with IC50 values 46.9 ± 3.7 and 35.2 ± 3.4 µM, respectively [22]. One new terpenoid, childinasterone A (260), was isolated from the fungus Daldinia Childiae collected from Kunming Botanical Garden, China. Compound 260 showed significant suppression of NO production in LPS-stimulated RAW264.7 cell activity with IC50 value of 21.2 µM, and weak activity against SMMC-7721 (inhibition rate 53.3%), MCF-7 (inhibition rate 64.6%) and SW480 (inhibition rate 67.0%), at the concentration of 40 µM [33]. One new compound, 22R-hydroxylanosta-7,9(11),24-trien-3-one (261), was isolated from the European ash-derived fungus Daldinia concentrica (the state of North Rhine Westphalia, Germany) [25]. One known compound, 22E-ergosta-4,6,8(14),22-tetraen-3-one (262), was isolated from the fermentation of the Euphorbia pekinensis endophytic fungus Daldinia eschscholtzii J11 [40]. One known compound, dankasterone A (263), was isolated from mangrove plant C. tagal-derived Daldinia eschscholzii MCZ-18 (Dong Zhai Gang-Mangrove Garden on Hainan Island, China) [26] (Figure 13).
2.6. Other Classes
Seventeen other class compounds were isolated from the fungi Daldinia spp., including eleven new compounds, of which eight compounds exhibited cytotoxicity, insect resistance activity and anti-inflammatory activities (Figure 14).
One new compound, 1-isopropy-2,7-dimethylnaphthhalene (264), was isolated from the fungus Daldinia sp. [24]. Five new compounds, coldols A–C (265–267), coldiol (268) and daldinrin I (269), and three known compounds (2S,4S,5R)-hept-6-en-2,4,5-triol (270), hypoxylonol H (271), 5-methyl-2-vinyltetrahydrofuran-3-ol (272), were isolated from the co-cultured fermentation products from C. pseudomajus and Daldinia eschscholtzii. Compound 269 exhibited anti-feeding activity against silkworms with an FDI of 97% at the concentration of 50 μg/cm2. Compounds 268 and 270–272 exhibited weak anti-feeding activity against silkworms with FDIs of 20%, 30%, 50% and 15%, respectively, at the concentration of 50 μg/cm2 [49]. One new compound, daldiniol F (273), was isolated from the medicinal plant Nelumbo nucifera endophytic fungus Daldinia sp. TJ403-LS1. Compound 273 showed potent BChE inhibitory activity (IC50, 23.33 ± 0.55 μM), better than the positive control neostigmine (IC50, 49.60 ± 6.10 μM). Molecular docking was performed to investigate the binding mode of compound 273 to BChE. Compound 273 formed hydrogen bonds with Glu197, and their benzene ring structure formed π-π conjugation with Trp82 and cation-π interactions with potassium ions [65]. Compound 273 was also isolated from mangrove B. sexangula var. Rhynchopetala-derived fungus Daldinia eschscholtzii HJ004 (the South China Sea, China) [46]. Compound 273 showed good BChE inhibitory activity, with an IC50 value of 23.33 ± 0.55 μM, better than the positive control neostigmine, with an IC50 value of 49.60 ± 6.10 μM [66]. One known phenolic compound, 2-phenylethyl-β-D-glucopyranoside (274), was isolated from the lichen-derived fungus Daldinia sp. CPCC 400770 (Laojunshan, Dali Bai autonomous prefecture, Yunnan province, China). Compound 274 exhibited significant anti-influenza A virus (IAV) activity with an IC50 value of 12.5 μM [45]. One new alkanol, 2,4,5-heptanetriol (275), together with one known compound, 6-heptene-2,4,5-triol (276), were isolated from the lichen Punctelia sp.-derived fungus Daldinia childiae (Cloak Mountain Scenic Area in Guizhou Province of China) [15]. Two new polyketide derivatives, eschschilin B (277) and dalditone A (278), and one known compound, eschscholin A (279), were isolated from mangrove Pluchea indica-derived fungus Daldinia eschschiltzii KBJYZ-1 (Zhanjiang, Guangdong Province, China). Compound 277 exhibited significant anti-inflammatory activity by inhibiting the expression of pP65 and p-IκBα proteins in LPS-induced RAW264.7 cells. The anti-inflammatory effect of compound 277 may be connected to the suppressed NF–κB signaling pathways in RAW264.7 cells with an IC50 value of 19.3 μM [48]. One new compound, daldinin C (280), was isolated from the fungus Daldinia concentrica (Laojunshan in Yunnan Province) [53] (Figure 14).

Figure 14.
Other classes produced by Daldinia species (264–280).
3. Conclusions
In this review, the sources, structural diversity and biological activity of secondary metabolites from the fungi Daldinia species are summarized, covering the period between January 1995 and June 2024. A total of 280 metabolites, including 196 new compounds, were obtained from the genus Daldinia. Remarkably, among them, 18 compounds (46–55, 74, 85, 213–214, 219–222) had novel skeleton structures. Furthermore, 280 compounds, along with their biological activities, producing strains and habitats, are summarized in Table 1. Among the total 47 taxa in the genus Daldinia, the fungi D. eschscholzii and D. concentrica are the two species that have been most extensively studied in chemical investigation. The vast metabolic diversity that may be encountered in a single species or strain is illustrated based on examples like D. eschscholtzii and D. concentrica. Additionally, 112 compounds have biological activities, such as anticancer, antiviral, antibacterial and antifungal activities, among others. The structures of secondary metabolites isolated from Daldinia sp. are also shown in Figure 2, Figure 3, Figure 4, Figure 5, Figure 6, Figure 7, Figure 8, Figure 9, Figure 10, Figure 11, Figure 12, Figure 13 and Figure 14. The structure type and bioactivity distribution of the compounds isolated from Daldinia sp. are also shown in Figure 15 and Figure 16.

Figure 15.
Structural diversity (left) and bioactivities (right) of compounds isolated from Daldinia sp. that were discovered from January 1995 to June 2024.

Figure 16.
Biological activities of secondary metabolites isolated from Daldinia sp.
The chemical structures of the 280 secondary metabolites from Daldinia species can mainly be classified into six types, including 21 terpenoids, 53 alkaloids, 125 polyketides, 58 polyphenols, 6 steroids and 17 other classes. However, among these 280 compounds, polyketides accounted for 44.64%, while terpenoids, alkaloids, polyphenols, steroids and other classes accounted for 7.50%, 18.93%, 20.72%, 2.14% and 6.07%, respectively (Figure 15).
As already mentioned in the previous sections, some strains of the Daldinia have already been targeted by chemical or molecular biology approaches. Interestingly, chemical and molecular biology methods, including chemical epigenetic modification, co-cultivation, OSMAC approach and genome mining, were employed to activate the silent/cryptic biosynthetic gene clusters within the genus Daldinia. Daldinsin (85) was isolated from Daldinia eschscholzii JC-15 based on the OSMAC strategy. Daldinones B (146) and E (147) were purified from the fungus Daldinia sp. treated with the epigenetic modifier SAHA. Dalestones A (185) and B (186) were obtained by the genomic mining of Daldinia eschscholzii. Eight new polyketides, daldinrin A–H (107–114), were isolated from the co-cultured fermentation products of D. eschscholtzii and C. pseudomajus. LC-MS/MS-based molecular networking has developed into a highly effective approach for the discovery of new natural products from complex mixtures. Six new tetramers (205–210), comprising the 5-methoxy-4-naphthol skeleton, were isolated from the fungus Daldinia childiae 047215 based on molecular networking analysis. The putative biosynthetic pathways of indolpolyketones A (46) and B (47), daldiconoid A (74), daldipyrenones A–C (75–77), daldiniaeschsones A (78) and B (79), (+)-orthosporin (116), nodulone (171), nodulones B (197) and C (198), (±) galewone (213 and 214) were also discussed. Daldinans B (62) and E (64) and entonalactam B (67) were synthesized.
Moreover, it is worth noting that nearly 40% (112 compounds) showed biological activities, including antimicrobial activities (24 compounds), cytotoxic activities (15 compounds), enzyme-inhibitory activities (17 compounds), antiviral activities (10 compounds), anti-inflammatory activities (15 compounds), antioxidant activities (16 compounds), anti-feedant activities (8 compounds) and other activities (7 compounds). Notably, antimicrobial (21.43%), enzyme-inhibitory (15.18%) and antioxidant activities (14.29%) represent the top three bioactivities (Figure 15 and Figure 16). It is important to highlight that 53 compounds exhibit potent activities. For example, a new indole alkaloid, (2R,4S)-indolchromin A (49), showed significant cytotoxic activity against the human breast cancer cell lines MDA-MB-231 with IC50 values of 27.9 nM, and against human breast cancer cell line MCF-7, with an IC50 value of 94.4 nM. Additionally, the samples were obtained from various environments: 39.64% from terrestrial plants, 24.64% from marine plants, 8.93% from animals and 26.79% from other resources.
In summary, species of Daldinia have been established as a significant reservoir of unique structures and a variety of secondary metabolites exhibiting a wide array of biological activities, thus uncovering their substantial, yet underutilized, potential in medicinal and agrochemical domains. Nonetheless, the scarcity of detailed pharmacological mechanisms hampers the application of most bioactive secondary metabolites. Therefore, future research should concentrate on elucidating pharmacological mechanisms, pharmacokinetics, medicinal chemistry, biosynthesis and other related areas to foster the advancement of innovative drug development.

Table 1.
The producing strains, habitats and bioactivities of secondary metabolites from Daldinia species.
Table 1.
The producing strains, habitats and bioactivities of secondary metabolites from Daldinia species.
| Compounds | Producing Strains | Habitats | Bioactivities | Refs |
|---|---|---|---|---|
| Methyl-7α-acetoxydeacetylbotryoloate (1) | D. concentrica (S0318) | Laojunshan, Yunnan Province, China | - | [14] |
| 7α-Acetoxydeacetylbotryenedial (2) | D. concentrica (S0318) | Laojunshan, Yunnan Province, China | - | [14] |
| 7α-Hydroxybotryenalol (3) | D. concentrica (S0318) | Laojunshan, Yunnan Province, China | - | [14] |
| 7,8-Dehydronorbotryal (4) | D. concentrica (S0318) | Laojunshan, Yunnan Province, China | - | [14] |
| 7α-Acetoxydehydrobotrydienal (5) | D. concentrica (S0318) | Laojunshan, Yunnan Province, China | - | [14] |
| 7α-Acetoxy-15-methoxy-10-O-methyldeacetyldihydrobotrydial (6) | D. concentrica (S0318) | Laojunshan, Yunnan Province, China | - | [14] |
| 7α-Hydroxy-10-O-methyldihydrobotrydial (7) | D. concentrica (S0318) | Laojunshan, Yunnan Province, China | - | [14] |
| 7-Hydroxy-16-O-methyldeacetyldihydrobotrydial-hydrate (8) | D. concentrica (S0318) | Laojunshan, Yunnan Province, China | - | [14] |
| 7-Hydroxydeacetyl-botryenalol (9) | D. concentrica (S0318) | Laojunshan, Yunnan Province, China | - | [14] |
| 7α-Hydroxydihydrobotrydial (10) | D. concentrica (S0318) | Laojunshan, Yunnan Province, China | - | [14] |
| Rel-(1S,4S,5R,7R,10R)-10-desmethyl-1-methyl-11-eudesmene (11) | D. childiae | Lichen Punctelia sp., Guizhou Province, China | Inhibition rate (α-amylase) of 15.99% at the concentration of 1.5 mg/mL | [15] |
| Daldiconoids B–G (12–17) | D. concentrica | Fruiting bodies, Yunnan Province, China | Inhibition of IL-1β, IL-6 and TNF-α in LPS-stimulated RAW264.7 cells comparable to dexamethasone at a concentration of 10 μM | [16] |
| Concentricol (18) | D. concentrica | - | - | [17] |
| Concentricols B–D (19–21) | D. concentrica | F. excelsior, North Rhine Westphalia, Germany | - | [18] |
| (11)-Cytochalasa-6(12), 13,19-triene-1,21-dione-7,18-dihydroxy-16,18-dimethyl-l0-phenyl-(7S*,13E,16S*,18S*,19E) (22) | Daldinia sp. | Quercus acutissima, Tokushima | - | [19] |
| (11)-Cytochalasa-6(12),13-diene-1,21-dione-7,18-dihydroxy-16,18-dimethyl-l0-phenyl-(7S*,13E,16S*,18R*) (23) | Daldinia sp. | Q. acutissima, Tokushima | - | [19] |
| (11)-Cytochalasa-6(12),13-diene-1,21-dione-7,18,19-trihydroxy-16,18-dimethyl-l0-phenyl-(7S*,13E,16S*,18S*,19R*) (24) | Daldinia sp. | Q. acutissima, Tokushima | - | [19] |
| (11)-Cytochalasa-6(12),13-diene-1,21-dione-7,18-dihydroxy-16,18-dimethyl-19-methoxy-l0-phenyl-(7S*,13E,16S*,18S*,19R*) (25) | Daldinia sp. | Q. acutissima, Tokushima | - | [19] |
| (11)-Cytochalasa-6(12),13-diene-1,21-dione-7,18-dihydroxy-16,18-dimethyl-19-acetoxy-10-phenyl-(7S*,13E,16S*,18S*,19R*) (26) | Daldinia sp. | Q. acutissima, Tokushima | - | [19] |
| (11)-Cytochalasa-6(12),13,19-triene-l,21-dione-16,18-dimethyl-7-hydroxy-10-phenyl-(7S*,3E,16S*,18R*,19E) (27) | Daldinia sp. | Q. acutissima, Tokushima | - | [20] |
| (11)-Cytochalasa-6(12),13-diene-1,21-dione-16,18-dimethyl-7-hydroxy-10-phenyl-(7S*,13E,16S*,18S*) (28) | Daldinia sp. | Q. acutissima, Tokushima | - | [20] |
| (11)-Cytochalasa-6(12),13-diene-1,21-dione-7,19-dihydroxy-16,18-dimethyl-10-phenyl-(7S*,13E,16S*,18R*,19R*) (29) | Daldinia sp. | Q. acutissima, Tokushima | - | [20] |
| (11)-Cytochalasa-6,13,19-triene-l,21-dione-18-hydroxy-16,18-dimethyl-10-phenyl-(6Z,13E,16S*,18S*,19E) (30) | Daldinia sp. | Q. acutissima, Tokushima | - | [20] |
| (11)-Cytochalasa-6,13,19-triene-1,21-dione-12,18-dihydroxy-16,18-dimethyl-10-phenyl-(6E,13E,16S*,18S*,19E) (31) | Daldinia sp. | Q. acutissima, Tokushima | - | [20] |
| (11)-Cytochalasa-6,13,19-triene-l,21-dione-17-hydroxy-16,18-dimethyl-10-phenyl(6Z,13E,16S*,17R,18S*,19E) (32) | Daldinia sp. | Q. acutissima, Tokushima | - | [20] |
| (11)-Cytochalasa-13,19-diene-1,21-dione-6,7-epoxy-18-hydroxy-16,18-dimethyl-10-phenyl-(7S*,13E,16S*,18S*,19E) (33) | Daldinia sp. | Q. acutissima, Tokushima | - | [20] |
| (11)-Cytochalas-13-ene-1,21-dione-6,7-epoxy-18,19-dihydroxy-16,18-dimethyl-l0-phenyl-(7S*,13E,16S*,18S*,19R*) (34) | Daldinia sp. | Q. acutissima, Tokushima | - | [20] |
| (11)-Cytochalasa-6(12),13,19-triene-1,17,21-trione-7,18-dihydroxy-16,18-dimethyl-10-phenyl-(7S*,13E,16S*,l8R*,19E) (35) | Daldinia sp. | Q. acutissima, Tokushima | - | [20] |
| (11)-Cytochalasa-5,13-19-triene-1,21-dione-7-hydroperoxy-17-hydroxy-16,18-dimethyl-10-phenyl-(5Z*,7S*,13E, 16S*,17R*,18S*,19E) (36) | Daldinia sp. | Q. acutissima, Tokushima | - | [20] |
| 22-Oxa-(12)-cytochalasa-6(12),13,19-triene-l,21-dione-7,18-dihydroxy-16,18-dimethyl-10-phenyl-(7S*,13E,16S*,18S*,19E) (37) | Daldinia sp. | Q. acutissima, Tokushima | - | [20] |
| [11]-Cytochalasa-6(12),13-diene-1,21-dione-7,19-dihydroxy-16,18-dimethyl-10-phenyl-(7S*,13E,16S*,18R*,19R*) (38) | D. vernicosa | Q. acutissima, Tokushima | - | [21] |
| Daldinin (39) | D. concentrica | Pumat National Park of Nghe An Province, Vietnam | IC50 (cytotoxicity) 11.4–13.5 µM | [22] |
| [11]-Cytochalasa-6(12),13-diene-1,21-dione-7,18,19-trihydroxy-16,18-dimethyl-10-phenyl-(7S*,13E,16S*,18S*,19R*) (40) | D. concentrica | Pumat National Park of Nghe An Province, Vietnam | IC50 (cytotoxicity) 23.0–58.2 µM | [22] |
| [11]-Cytochalasa-6(12),13diene-1,21 dione-7,18-dihydroxy-16,18-dimethyl-10-phenyl-(7S*,13E,16S*,18R*) (41) | D. concentrica | Pumat National Park of Nghe An Province, Vietnam | IC50 (cytotoxicity) 23.0–58.2 µM | [22] |
| [11]-Cytochalasa-5(6),13-diene-1,21-dione-7,18-dihydroxy-16,18-dimethyl-10-phenyl-(7S*,13E,16S*,18R*) (42) | D. eschscholtzii HJ001 | Bruguiera sexangula var. rhynchopetala, South China Sea, China | MIC (antibacterial) 50 µg/mL | [23] |
| 21-(Acetyloxy)-6,13,14-trihydroxy-16,18-dimethyl-10-phenyl[11]cytochalasa-7,19-dien-1-one (43) | D. concentrica | Laojunshan, Yunnan Province, China | - | [24] |
| Phenochalasin B (44) | D. concentrica | F. excelsior, North Rhine Westphalia, Germany | - | [25] |
| Cytochalasin O (45) | D. eschscholzii MCZ-18 | C. tagal, Hainan Province, China | - | [26] |
| Indolpolyketones A (46) and B (47) | D. escosholzii | T. aridifolia | IC50 (antiviral) 45.2, 31.4 µM | [27] |
| (2S,4R)-Indolchromin A (48) | D. eschscholzii | T. aridifolia | MIC (antibacterial) 2.1–6.4 µM | [28] |
| (2R,4S)-Indolchromin A (49) | D. eschscholzii | T. aridifolia | MIC (antibacterial) 1.3–6.2 µM, IC50 (cytotoxicity) 27.9–94.4 nM | [28] |
| (2S,4S)-Indolchromin A (50) | D. eschscholzii | T. aridifolia | - | [28] |
| (2R,4R)-Indolchromin A (51) | D. eschscholzii | T. aridifolia | - | [28] |
| (2S,4R)-Indolchromin B (52) | D. eschscholzii | T. aridifolia | - | [28] |
| (2R,4S)-Indolchromin B (53) | D. eschscholzii | T. aridifolia | MIC (antibacterial) 6.2–6.7 µM | [28] |
| (2S,4S)-Indolchromin B (54) | D. eschscholzii | T. aridifolia | IC50 (cytotoxicity) 131.2 nM | [28] |
| (2R,4R)-Indolchromin B (55) | D. eschscholzii | T. aridifolia | - | [28] |
| Dalesindoloids A–B (56–57) | D. eschscholzii | T. aridifolia | IC50 (cytotoxicity) 1.0–7.4 µM | [29] |
| 3-(1H-indole-3ylmethyl)-2-oxindole (58) | D. eschscholzii | T. aridifolia | - | [29] |
| Daldinans B–C (59–60) | D. concentrica | Yamanashi Prefecture, Japan | - | [30] |
| Daldinans A–B (61–62) | D. concentrica | Odaesan National Park, Korea | IC50 (antioxidant) 12.62–39.67 µM | [31] |
| Daldinans D–G (63–66) | D. concentrica | Odaesan National Park, Korea | IC50 (antioxidant) 2.65–3.50 µM | [31] |
| Entonalactam B (67) | Daldinia sp. | - | - | [32] |
| (±) Childinins C (68) | D. childiae | Kunming Botanical Garden, China | - | [33] |
| Daldinin A (69) | D. concentrica | Muju county, Jeonbuk province, Korea | IC50 (radical scavenging) 10.4 μM | [34] |
| 1-(3-Indolyl)-2R,3-dihydroxypropan-1-one (70) | D. eschschilzii | Scaevola serica, Hainan Province, China | - | [35] |
| 3-Ethyl-2,5-pyrazinedipropanoic acid (71) | D. eschschilzii | S. serica, Hainan Province, China | - | [35] |
| 2,5-Pyrazinedipropanoic acid (72) | D. eschschilzii | S. serica, Hainan Province, China | - | [35] |
| Cyclo-(Phe-Tyr) (73) | D. eschschilzii | S. serica, Hainan Province, China | - | [35] |
| Daldiconoid A (74) | D. concentrica | Fruiting bodies, Yunnan Province, China | Inhibition of IL-1β, IL-6 and TNF-α in LPS stimulated RAW264.7 cells comparable to those of dexamethasone at a concentration of 10 μM | [16] |
| Daldipyrenones A–C (75–77) | D. pyrenaica 047188 | Lichen Myelochroa aurulenta, Korea | EC50 (antimelanogenic) 3.36 mM | [36] |
| Daldiniaeschsones A (78) and B (79) | D. eschscholtzii SDBRCMUNKC745 | Cinnamomum bejolghota, Chiang Mai, Thailand | IC50 (α-glucosidase inhibitory) 0.16–0.23 mM | [37] |
| Nodulisporin G (80) | D. eschscholzii | T. aridifolia, Nanjing, China | - | [38] |
| 8-O-methylnodulisporin F (81) | D. eschscholtzii HJ004 | B. sexangula, South China Sea, China | MIC (antibacterial) 6.22–12.5 µg/mL | [39] |
| Nodulisporin H (82) | D. eschscholtzii HJ004 | B. sexangula, South China Sea, China | MIC (antibacterial) 6.22–12.5 µg/mL | [39] |
| Daldiniside A (83) | D. eschschilzii | S. serica, Hainan Province, China | - | [35] |
| 7-O-α-D-ribosyl-5-hydroxy-2-propylchromone (84) | D. eschscholtzii J11 | E. pekinensis, Yunnan Province, China | - | [40] |
| Daldinsin (85) | D. eschscholzii JC-15 | D. officinale, Yunnan, Province, China | Inhibition rate (acetylcholinesterase) of 38.8% at the concentration of 50 µM | [41] |
| Karimanone (86) | D. eschscholtzii KJMT FP4.1 | Xestospongia sp., Karimonjawa National Park | MIC (antibacterial) 125 µg/mL | [42] |
| (S)-5-Hydroxy-2-methyl-4-chromanone (87) | D. eschscholtzii KJMT FP4.1 | Xestospongia sp., Karimonjawa National Park | MIC (antibacterial) 62.5 µg/mL | [42] |
| 5,7-Dihydroxy-2-methyl-4-chromanone (88) | D. eschscholtzii KJMT FP4.1 | Xestospongia sp., Karimonjawa National Park | MIC (antibacterial) 125 µg/mL | [42] |
| (R)-5-hydroxy-8-methoxy-2-methylchroman-4-one (89) | D. eschscholtzii | Broad-leaved tree, Deyang City, Sichuan Province, China | - | [43] |
| 7-Hydroxy-5-methoxy-2,3-dimethylchromone (90) | D. eschscholtzii HJ004 | B. sexangula var. rhynchopetala, Hainan Province, China | IC50 (α-glucosidase inhibitory) 13.0 µM | [44] |
| 5-Methoxy-2-propanone (91) | D. eschscholtzii HJ004 | B. sexangula var. rhynchopetala, Hainan Province, China | - | [44] |
| 7-Ethyl-8-hydroxy-6-methoxy-2,3-dimethylchromone (92) | D. eschscholtzii HJ004 | B. sexangula var. rhynchopetala, Hainan Province, China | - | [44] |
| 2,3-Dihydro-5-methoxy-2-methylchromen-4-one (93) | D. eschscholtzii HJ004 | B. sexangula var. rhynchopetala, Hainan Province, China | IC50 (α-glucosidase inhibitory) 15.0 µM | [44] |
| 8-Methoxy-2-methyl-4H-1-benzopyran-4-one (94) | D. eschscholtzii HJ004 | B. sexangula var. rhynchopetala, Hainan Province, China | - | [44] |
| 7-Hydroxy-2,5-dimethyl-4H-1-benzopyran-4-one (95) | D. eschscholtzii HJ004 | B. sexangula var. rhynchopetala, Hainan Province, China | - | [44] |
| (5R,7R)-5,7-Dihydroxy-2-methyl-5,6,7,8-tetrahydro-4H-chromen-4-one (96) | Daldinia sp. CPCC 400770 | Laojunshan, Dali Bai Autonomous Region, Yunnan Province, China | IC50 (antiviral) 16.1 µM | [45] |
| (5R,7R)-5,7-Dihydroxy-2-copy-5,6,7,8-tetrahydro-4H-chromen-4-one (97) | Daldinia sp. CPCC 400770 | Laojunshan, Dali Bai Autonomous Region, Yunnan Province, China | - | [45] |
| (5R,7R)-5,7-Dihydroxy-2-methyl-5,6,7,8-tetrahydro-4H-chromen-4-one (98) | Daldinia sp. CPCC 400770 | Laojunshan, Dali Bai Autonomous Region, Yunnan Province, China | IC50 (antiviral) 9.0 µM | [45] |
| (5R,7S)-5,7-dihydroxy-2-methyl-5,6,7,8-tetrahydro-4H-chromen-4-one (99) | Daldinia sp. CPCC 400770 | Laojunshan, Dali Bai Autonomous Region, Yunnan Province, China | - | [45] |
| 8-Ethyl-7-hydroxy-5-carboxyl-2,3-dimethylchromone (100) | D. eschscholtzii HJ004 | B. sexangula, South China Sea, China | IC50 (antioxidant) 195.03 µM | [46] |
| 5-Hydroxy-2-methyl-4H-chromen-4-one (101) | D. eschscholtzii HJ004 | B. sexangula, South China Sea, China | IC50 (antioxidant) 20.79 µM | [46] |
| 5,8-Dihydroxy-2-methylchromone (102) | D. eschscholtzii HJ004 | B. sexangula, South China Sea, China | IC50 (antioxidant) 8.90 µM | [46] |
| 5,7-Dihydroxy-2-propylchromone (103) | D. eschscholtzii HJ004 | B. sexangula, South China Sea, China | IC50 (antioxidant) 5.57 µM | [46] |
| 3,5-Dihydroxy-2-methyl-4H-chromen-4-one (104) | D. eschscholtzii A630 | P. cablin , Guangdong Province, China | - | [47] |
| (2R,4R)-3,4-dihydro-5-methoxy-2-methyl-2H-1-benzopyran-4-ol (105) | D. eschschiltzii KBJYZ-1 | P. indica, Guangdong Province, China | - | [48] |
| 5-Hydroxy-8-methoxy-2-methyl-4H-1-benzopyran-4-one (106) | D. eschscholzii MCZ-18 | C. tagal, Hainan Province, China | - | [26] |
| Daldinrins A–H (107–114) | D. eschscholtzii | Colletotrichum sinensis, Yunnan Province, China | MIC (antibacterial) 1.0 µg/mL | [49] |
| (+)-Mellein (115) | D. eschscholtzii SDBRCMUNKC745 | C. bejolghota, Chiang Mai, Thailand | IC50 (α-glucosidase inhibitory) 0.76 mM | [37] |
| (+)-Orthosporin (116) | D. eschscholtzii | P. exul , Chiang Mai, Thailand | CC50 (cytotoxicity) 89.0 µM | [50] |
| (3R)-Methyl-6,8-dihydroxy-7-methyl-3,4-dihydroisocoumarin (117) | D. eschscholtzii J11 | E. pekinensis, Yunnan Province, China | - | [40] |
| 6-Hydroxymellein (118) | D. eschscholtzii J11 | E. pekinensis, Yunnan Province, China | - | [40] |
| 2-Acetyl-7-methoxybenzofuran (119) | D. eschscholzii MCZ-18 | C. tagal, Hainan Province, China | MIC (antibacterial) 12.5–25 µg/mL | [26] |
| 4,8-Dimethoxy-1H-isochromen-1-one (120) | D. eschscholzii MCZ-18 | C. tagal, Hainan Province, China | - | [26] |
| (+)-Citreoisocoumarin (121) | D. eschscholzii MCZ-18 | C. tagal, Hainan Province, China | - | [26] |
| Daldinisides B–C (122–123) | D. eschschilzii | S. serica, Hainan Province, China | - | [35] |
| 4-Methoxy-5-carboxymethoxy-6-pentyl-2H-pyran-2-one (124) | D. concentrica | European ash, Germany | - | [25] |
| Childinins A (125), F–G (126–127) | D. childiae | Kunming, Yunnan Province, China | - | [33] |
| Daldineschscin B (128) | D. eschscholtzii J11 | E. pekinensis, Yunnan Province, China | - | [40] |
| Helicascolides D (129) and E (130) | D. eschscholtzii HJ004 | B. sexangula, Hainan Province, China | - | [44] |
| Helicascolides A (131) and B (132) | D. eschscholtzii HJ004 | B. sexangula, Hainan Province, China | IC50 (α-glucosidase inhibitory) 16 μM | [44] |
| Helicascolide G (133) | D. eschscholtzii HJ004 | B. sexangula, South China Sea, China | - | [46] |
| Helicascolide A (134) | D. eschscholzii | Gracilaria sp., South Sulawesi Island, Indonesia | Against the plant pathogenic fungus | [51] |
| Daldinolides A–B (135–136) | D. concentrica | Yamanashi Prefecture, Japan | - | [30] |
| Concentricolide (137) | D. concentrica | Yunnan Province, China | EC50 (inhibited HIV-1) 0.31 µg/mL, EC50 (exhibited the blockage) 0.83 µg/mL | [52] |
| Daldinins A–B (138–139) | D. concentrica | Yunnan Province, China | - | [53] |
| 4-Isoochracein (140) | D. concentrica | Yunnan Province, China | - | [53] |
| Hydroxyisoochracein (141) | D. concentrica | Yunnan Province, China | - | [53] |
| Curuilignan D (142) | D. concentrica | European ash, North Rhine Westphalia, Germany | - | [25] |
| Daldinione E (143) | D. eschscholtzii HJ004 | B. sexangula, South China Sea, China | - | [44] |
| (E)-6-(non3-en-1-yl)-2H-pyran-2-one (144) | D. eschscholtzii | Broad-leaved tree, Sichuan Province, China | - | [43] |
| Daldinone A (145) | D. concentrica | European ash, North Rhine Westphalia, Germany | - | [25] |
| Daldinone B (146) | Daldinia sp. | C. cainito | IC50 (radical scavenging) 3.1 μM | [54] |
| Daldinone E (147) | Daldinia sp. | C. cainito | IC50 (radical scavenging) 3.6 μM | [54] |
| Daldinones F–G (148–149) | D. eschscholtzii | P. exul , Chiang Mai, Thailand | - | [50] |
| Daldinones C–D (150–151) | D. eschscholtzii | P. exul , Chiang Mai, Thailand | IC50 (cytotoxicity) 41.0–49.5 µM | [50] |
| Dalmanol C (152) | D. eschscholzii | Tenodera aridifolia, Nanjing, China | - | [38] |
| Daldinone F (153) | D. eschscholzii | T. aridifolia, Nanjing, China | IC50 (cytotoxicity) 9.59 µM | [38] |
| 3,4,5-Trihydroxy-1-tetralone (154) | D. concentrica | European ash, North Rhine Westphalia, Germany | - | [25] |
| (1R,4R)-5-methoxy-1,2,3,4-tetrahydronaphthalene-1,4-dio (155) | D. eschschiltzii KBJYZ-1 | P. indica, Guangdong Province, China | - | [48] |
| (+)-Regiolone (isosclerone) (156) | D. eschscholtzii SDBRCMUNKC745 | C. bejolghota, Chiang Mai, Thailand | IC50 (α-glucosidase inhibitory) 0.85 mM | [37] |
| (+)-3,4-Dihydro-3,4,8-trihydroxy-1(2H)-naphthalenone (157) | D. eschscholtzii SDBRCMUNKC745 | C. bejolghota, Chiang Mai, Thailand | IC50 (α-glucosidase inhibitory) 0.55 mM | [37] |
| Daldiniones C–D (158–159) | D. eschscholtzii HJ004 | B. sexangula, the South China Sea, China | - | [44] |
| 4R-(O)-methylsclerone (160) | D. eschscholtzii HJ004 | B. sexangula, the South China Sea, China | - | [44] |
| (-)-Cis-(3R*,4S*)-3,4,8-trihydroxy-6,7-dimethyl-3,4-dihydronaphthalen-1(2H)-one (161) | D. eschscholtzii HJ004 | B. sexangula, the South China Sea, China | IC50 (α-glucosidase inhibitory) 21 μM | [44] |
| (4R*)-4,8-dihydroxy-3-hydro-5-methoxy-1-naphthhthalenone (162) | Daldinia sp. | C. tagal, Hainan Province, China; oak leaves, Tokushima | - | [21,26] |
| 4,6,8-Trihydroxide-3,4-dihydronaphthhalen-1 (2H)-one (163) | D. eschscholzii | S. sericea, Hainan Province, China | - | [35] |
| (-)-Regiolone (164) | D. childiae | Lichen Punctelia sp, Guizhou Province, China | - | [15] |
| (1R, 4R)-5-methoxy-1,2,3,4-tetrahydronaphthalene-1,4-dio (165) | D. eschschiltzii KBJYZ-1 | P. indica , Guangdong Province, China | - | [48] |
| Daldinrin K (166) | D. eschscholtzii | C. sinensis, Yunnan Province, China | Anti-feedant activities with feeding deterrence index of 81% | [49] |
| Dalesconoside F (167) | D. eschscholzii MCZ-18 | C. tagal, Hainan Province, China | - | [26] |
| Nodulisporone (168) | D. eschscholzii MCZ-18 | C. tagal, Hainan Province, China | - | [26] |
| Xylariol A (169) | D. eschscholzii MCZ-18 | C. tagal, Hainan Province, China | - | [26] |
| (4R)-3,4-dihydro-4,5-dihydroxynaphthalen-1(2H)-one (170) | D. eschscholzii MCZ-18 | C. tagal, Hainan Province, China | MIC (antimicrobial) 25–50 µg/mL | [26] |
| Nodulone (171) | D. eschscholtzii | P. exul , Chiang Mai, Thailand | - | [50] |
| Daldiquinone (172) | D. concentrica | Yamanashi Prefecture, Japan | IC50 (antiangiogenesis activity) 7.5 µM | [30] |
| Dalditene A (173) | D. eschschiltzii KBJYZ-1 | P. indica ,Guangdong Province, China | IC50 (anti-inflammatory) 12.9 µM | [48] |
| Dalesconoside D (174) | D. eschscholzii MCZ-18 | C. tagal, Hainan Province, China | - | [26] |
| Dalesconoside E (175) | D. eschscholzii MCZ-18 | C. tagal, Hainan Province, China | - | [26] |
| 5-Hydroxy-2-methoxy-6,7-dimethyl-1,4-naphthoquinone (176) | D. eschscholtzii HJ004 | B. sexangula, South China Sea, China | MIC (antibacterial) 12.5 µg/mL | [39] |
| 5-Hydroxy-2-methoxynaphtho[9–c]furan-1,4-dione (177) | D. eschscholtzii HJ004 | B. sexangula, South China Sea, China | IC50 (α-glucosidase inhibitory) 5.7 µg/mL | [39] |
| 3-Alkyl-5-methoxy-2-methyl-1,4-benzoquinones,3-heneicosyl (178), | D. concentrica | Laojunshan, Yunnan Province, China | - | [55] |
| 3-Docosyl-5-methoxy-2-methyl-1,4-benzoquinone (179) | D. concentrica | Laojunshan, Yunnan Province, China | - | [55] |
| 5-Methoxy-2-methyl-3-tricosyl-1,4-benzoquinone (180) | D. concentrica | Laojunshan, Yunnan Province, China | - | [55] |
| Daldinrin J (181) | D. eschscholtzii | C. sinensis, Yunnan Province, China | Anti-feedant activities with feeding deterrence index of 81% | [49] |
| 2-Acetyl-7-methoxybenzofuran (182) | D. eschscholtzii HJ004 | B. sexangula, South China Sea, China | IC50 (α-glucosidase inhibitory) 1.1 µg/mL | [39] |
| Daldisones A–B (183–184) | Daldinia sp. CPCC 400770 | - | IC50 (antiviral) 16.0–7.4 µM, MIC (antibacterial) 16.0–32 µg/mL | [56] |
| Dalestones A–B (185–186) | D. eschscholzii | - | Inhibition of IL-1β, IL-6 and TNF-α in LPS stimulated RAW264.7 cells comparable to those of dexamethasone at a concentration of 20 μM | [57] |
| Daldineschscin A (187) | D. eschscholtzii J11 | E. pekinensis, Yunnan Province, China | - | [40] |
| Xylariphilone (188) | D. eschscholtzii J11 | E. pekinensis, Yunnan Province, China | IC50 (radical scavenging) 49.13 μM | [40] |
| Dalesconoside B (189) | D. eschscholzii MCZ-18 | C. tagal, Hainan Province, China | - | [26] |
| Fusaraisochromenone (190) | D. eschscholzii MCZ-18 | C. tagal, Hainan Province, China | MIC (antibacterial) 6.25–25 µg/mL | [26] |
| Childinin B (191) | D. childiae | Kunming Botanical Garden, China | MIC90 (antibacterial) 54.9 µg/mL | [33] |
| Daldiniones A–B (192–193) | D. eschscholtzii HJ004 | B. sexangula, Hainan Province, China | - | [44] |
| Eschscholin A (194) | D. eschscholtzii A630 | P. cablin, Guangdong Province, China | - | [47] |
| 3-Ene-2-methyl-2H-1-benzopyran-5-ol (195) | D. eschscholtzii A630 | P. cablin, Guangdong Province, China | - | [47] |
| Daldionin (196) | D. eschscholtzii | P. exul , Chiang Mai, Thailand | Antiproliferative activity against HUVEC (GI50 98.4 μM) and K-562 cell lines (GI50 85.5 μM) | [50] |
| Nodulones B–C (197–198) | D. eschscholtzii | P. exul , Chiang Mai, Thailand | - | [50] |
| Pyranlyketide (199) | D. eschscholtzii | C. sinensis, Yunnan Province, China | - | [49] |
| 1,1′,3′,3″-Ternaphthalene-5,5′,5″-trimethoxy-4,4′,4″-triol (200) | D. childiae 047215 | Lichen P. adaugescens, South Korea | - | [58] |
| 3,1′,3′,3″-Ternaphthalene-5,5′,5″-trimethoxy-4,4′,4″-triol (201) | D. childiae 047215 | Lichen P. adaugescens, South Korea | IC50 (adiponectin synthesis-promoting activity) 30.8 μM | [58] |
| 1,1′,3′,1″-Ternaphthalene-5,5′,5″-trimethoxy-4,4′,4″-triol (202) | D. childiae 047215 | Lichen P. adaugescens, South Korea | - | [58] |
| 3,1′,3′,1″-Ternaphthalene-5,5′,5″-trimethoxy-4,4′,4″-triol (203) | D. childiae 047215 | Lichen P. adaugescens, South Korea | - | [58] |
| Nodulisporin A (204) | D. childiae 047215 | Lichen P. adaugescens, South Korea | IC50 (adiponectin synthesis-promoting activity) 15.2 μM | [58] |
| 1,1′,3′,3″,1″,1‴-Quaternaphthalene-5,5′,5″,5‴-tetramethoxy-4,4′,4″4‴-tetraol (205) | D.childiae 047219 | Lichen P. adaugescens, Hannah Mountain in Jeju Island, South Korea | - | [59] |
| 1,1′,3′,1″,3″,3‴-Quaternaphthalene-5,5′,5″,5‴-tetramethoxy-4,4′,4″4‴-tetraol (206) | D. childiae 047219 | Lichen P. adaugescens, Hannah Mountain in Jeju Island, South Korea | - | [59] |
| 3,3′,1′,1″,3″,3‴-Quaternaphthalene-5,5′,5″,5‴-tetramethoxy-4,4′,4″4‴-tetraol (207) | D. childiae 047219 | Lichen P. adaugescens, Hannah Mountain in Jeju Island, South Korea | - | [59] |
| 1,1′,3′,3″,1″,3‴-Quaternaphthalene-5,5′,5″,5‴-tetramethoxy-4,4′,4″4‴-tetraol (208) | D. childiae 047219 | Lichen P. adaugescens, Hannah Mountain in Jeju Island, South Korea | - | [59] |
| 3,1′,3′,1″,3″,3‴-Quaternaphthalene-5,5′,5″,5‴-tetramethoxy-4,4′,4″4‴-tetraol (209) | D. childiae 047219 | Lichen P. adaugescens, Hannah Mountain in Jeju Island, South Korea | - | [59] |
| 3,1′,3′,3″,1″,3‴-Quaternaphthalene-5,5′,5″,5‴-tetramethoxy-4,4′,4″4‴-tetraol (210) | D. childiae 047219 | Lichen P. adaugescens, Hannah Mountain in Jeju Island, South Korea | - | [59] |
| Nodulisporins B (211) and E (212) | D. childiae 047219 | Lichen P. adaugescens, Hannah Mountain in Jeju Island, South Korea | Inhibition rate (NO on LPS-induced RAW cells) of 50% at the concentration of 25–50 µM | [59] |
| (±)-Galewone (213–214) | D. eschscholzii IFB-TL01 | T. aridifolia | IC50 (reduced cell viability) 3.73–10.10 μM | [60] |
| (±)-Spirodalesol (215–216) | D. eschscholzii | T. aridifolia | IC50 (suppressed secretion of IL-1β) 0.67–0.70 μM | [61] |
| Selesconol (217) | D. eschscholzii IFB-TL01 | T. aridifolia | - | [62] |
| (±)-Dalesconol A (218–219) | D. eschscholzii IFB-TL01 | T. aridifolia | - | [63] |
| (±)-Dalesconol B (220–221) | D. eschscholzii IFB-TL01 | T. aridifolia | - | [63] |
| Dalesconosides A and C (222–223) | D. eschscholzii MCZ-18 | C. tagal, Hainan Province, China | MIC (antibacterial) 12.5–25 µg/mL | [26] |
| 8-Methoxynaphthalen-1-ol (224) | D. loculata | Lichen, Laojunshan, Yunnan Province, China | - | [64] |
| Daldiniol G (225) | Daldinia sp. TJ403-LS1 | A. roxburghi, Hubei Province, China | IC50 (BChE inhibitory activity) 15.53 μM | [65] |
| 1,8-Dimethoxynaphthalene (226) | D. eschscholtzii J11 | E. pekinensis, Yunnan Province, China | - | [40] |
| 1,3,8-Trimethoxynaphtho[9–c]furan (227) | D. eschscholtzii HJ004 | B. sexangula, South China Sea, China | - | [39] |
| 4:5:4′:5′-Tetrahydroxy-1:1′-binaphthyl (228) | D. concentrica | European ash, North Rhine Westphalia, Germany | - | [25] |
| Daldiniols A–D (229–232) | Daldinia sp. TJ403-LS1 | A. roxburghi, Hubei Province, China | IC50 (BChE inhibitory activity) 6.93 μM | [65] |
| 4-Hydroxy-3-(3-methylbut-3-en-l-ynyl) benzyl alcohol (233) | Daldinia sp. TJ403-LS1 | A. roxburghi, Hubei Province, China | - | [65] |
| 4-Methoxy-3-(3-methylcut-3-en-l-ynyl) benzyl alcohol (234) | Daldinia sp. TJ403-LS1 | A. roxburghi, Hubei Province, China | IC50 (BChE inhibitory activity) 16.00 μM | [65] |
| Daldiniol E (235) | Daldinia sp. TJ403-LS1 | A. roxburghi, Wuhan, Hubei Province, China | - | [65] |
| Dalditone B (236) | D. eschschiltzii KBJYZ-1 | P. indica , Guangdong Province, China | - | [48] |
| Orcinotriol (237) | D. eschschilzii | S. serica, Hainan Province, China | - | [35] |
| 4-(2-Hydroxyethyl) phenol (238) | D. loculata | Laojunshan, Yunnan Province, China | - | [65] |
| Daldins A–C (239–241) | D. concentrateca S0318 | Laojunshan, Yunnan Province, China | - | [66] |
| 2-Hydroxymethyl-3-(1-hydroxypropyl) phenol (242) | D. concentrateca S0318 | Laojunshan, Yunnan Province, China | - | [66] |
| Daldinrin L (243) | D. eschscholtzii | C. sinensis, Yunnan Province, China | Anti-feedant activity with feeding deterrence index of 70% at concentrations of 50 μg/cm2 | [49] |
| Stachyline C (244) | Daldinia sp. CPCC 400770 | Laojunshan, Yunnan Province, China | - | [45] |
| 3-Methoxy-4-hydroxyphenylethanol (245) | Daldinia sp. CPCC 400770 | Laojunshan, Yunnan Province, China | - | [45] |
| 3-Hydroxy-4-methoxy-phenylethanol (246) | Daldinia sp. CPCC 400770 | Laojunshan, Yunnan Province, China | - | [45] |
| Childinin D (247) | D. childiae | Kunming Botanical Garden, China | - | [33] |
| Childinin E (248) | D. childiae | Kunming Botanical Garden, China | - | [33] |
| 2-(Hydroxymethyl)-3-(1-hydroxypropyl) phenol (249) | D. concentrica | Laojunshan, Yunnan Province, China | - | [53] |
| AB5046A (250) | D. eschscholtzii KJMT FP4.1 | Xestospongia sp., Karimonjawa National Park | MIC (antibacterial) 125 µg/mL | [42] |
| (3S)-3,8-dihydroxy-6,7-dimethyl-α-tetralone (251) | D. eschscholtzii PSU-STD57 | B. gymnorrhiza, Suratthani province, Thailand | - | [67] |
| 3-Hydroxy-1-(2,6-dihydroxyphenyl)butan-1-one (252) | D. eschscholtzii J11 | E. pekinensis, Yunnan Province, China | IC50 (radical scavenging) 43.66 μM | [40] |
| 1-(2,6-Dihydroxy-phenyl)butan-1-one (253) | D. eschscholtzii J11 | E. pekinensis, Yunnan Province, China | IC50 (radical scavenging) 28.08 μM | [40] |
| 1-(2,6-Dihydroxyphenyl) ethan-1-one (254) | D. eschscholtzii J11 | E. pekinensis, Yunnan Province, China | - | [40] |
| Daldispols A–C (255–257) | Daldinia sp. CPCC 400770 | Laojunshan, Yunnan Province, China | IC50 (antiviral) 12.7–6.4 µM | [45] |
| Ergosterol (258) | D. concentrica | Pumat National Park of Nghe An Province, Vietnam | IC50 (cytotoxicity) 21.5–43.6 µM | [22] |
| Ergosterol peroxide (259) | D. concentrica | Pumat National Park of Nghe An Province, Vietnam | IC50 (cytotoxicity) 46.9–35.2 µM | [22] |
| Childinasterone A (260) | D. childiae | Kunming Botanical Garden, China | IC50 (anti-NO activity) 21.2 µM | [33] |
| Daldinialone (22R-hydroxylanosta-7,9 (11), 24-trien-3-one) (261) | D. concentrica | European ash, North Rhine Westphalia, Germany | - | [25] |
| 22E-ergosta-4,6,8(14),22-tetraen-3-one (262) | D. eschscholtzii J11 | E. pekinensis, Yunnan Province, China | - | [40] |
| Dankasterone A (263) | D. eschscholzii MCZ-18 | C. tagal, Hainan Province, China | - | [26] |
| 1-Isopropy-2,7-dimethylnaphthhalene (264) | D. concentrica | Laojunshan, Yunnan Province, China | - | [24] |
| Coldols A–C (265–267) | D. eschscholtzii | C. sinensis, Yunnan Province, China | - | [49] |
| Coldiol (268) | D. eschscholtzii | C. sinensis, Yunnan Province, China | Anti-feedant activity with feeding deterrence index of 20% at concentrations of 50 μg/cm2 | [49] |
| Daldinrin I (269) | D. eschscholtzii | C. sinensis, Yunnan Province, China | Anti-feedant activity with feeding deterrence index of 97% at concentrations of 50 μg/cm2 | [49] |
| (2S,4S,5R)-hept-6-en-2,4,5-triol (270) | D. eschscholtzii | C. sinensis, Yunnan Province, China | Anti-feedant activities with feeding deterrence index of 30% at concentrations of 50 μg/cm2 | [49] |
| Hypoxylonol H (271) | D. eschscholtzii | C. sinensis, Yunnan Province, China | Anti-feedant activities with feeding deterrence index of 50% at concentrations of 50 μg/cm2 | [49] |
| 5-Methyl-2-vinyltetrahydrofuran-3-ol (272) | D. eschscholtzii | C. sinensis, Yunnan Province, China | Anti-feedant activities with feeding deterrence index of 15% at concentrations of 50 μg/cm2 | [49] |
| 2-Phenylethyl-β-D-glucopyranoside (273) | Daldinia sp. TJ403-LS1, D. eschscholtzii HJ004 | A. roxburghi, Hubei Province, B. sexangula, South China Sea, China | IC50 (BChE inhibitory activity) 23.33 μM | [46,65] |
| Daldiniol F (274) | Daldinia sp. CPCC 400770 | Laojunshan, Yunnan Province, China | IC50 (antiviral) 12.5 µM | [45] |
| 2,4,5-Heptanetriol (275) | D. childiae | Lichen Punctelia sp, Guizhou Province, China | - | [15] |
| 6-Heptene-2,4,5-triol (276) | D. childiae | Lichen Punctelia sp., Guizhou Province, China | - | [15] |
| Eschschilin B (277) | D. eschschiltzii KBJYZ-1 | P. indica , Guangdong Province, China | IC50 (anti-inflammatory) 19.3 µM | [48] |
| Dalditone A (278) | D. eschschiltzii KBJYZ-1 | P. indica , Guangdong Province, China | - | [48] |
| Eschscholin A (279) | D. eschschiltzii KBJYZ-1 | P. indica , Guangdong Province, China | - | [48] |
| Daldinin C (280) | D. concentrica | Laojunshan, Yunnan Province, China | - | [53] |
Author Contributions
C.Z. and G.H. conceived and revised this article; M.Y. prepared and wrote the original draft; S.C., J.S., W.C. and Y.Q. conducted the literature analysis; J.L., S.Q., J.F., R.W. and F.L. reviewed and edited this article. All authors have read and agreed to the published version of the manuscript.
Funding
This work was supported by the National Natural Science Foundation of China (Nos. 32160108 and 2217702), the Key Research and Development Program of Hainan Province (No. ZDYF2024SHFZ116 and ZDYF2021SHFZ270), the Team Innovation Center for Academicians of Hainan Province, the Specific Research Fund for the Innovation Center of Hainan Province Academicians (No. YSPTZX202309), the Key Science and Technology Program of Hainan Province (No. ZDKJ202008) and Innovation Experiment Project for College Students (NO. hsyx2022-1).
Conflicts of Interest
The authors declare no competing financial interests.
References
- Zheng, R.H.; Li, S.J.; Zhang, X.; Zhao, C.Q. Biological activities of some new secondary metabolites isolated from endophytic fungi: A review study. Int. J. Mol. Sci. 2021, 22, 959. [Google Scholar] [CrossRef] [PubMed]
- Kong, D.W.; Niu, R.C.; Mao, Y.Z.; Liu, L.L. Research progress on active metabolites of endophytes. Heilongjiang Agric. Sci. 2019, 12, 151–154. [Google Scholar]
- Wethalawe, A.N.; Alwis, Y.V.; Udukala, D.N.; Paranagama, P.A. Antimicrobial compounds isolated from endolichenic fungi: A review. Molecules 2021, 26, 3901. [Google Scholar] [CrossRef]
- Kellogg, J.J.; Raja, H.A. Endolichenic fungi: A new source of rich bioactive secondary metabolites on the horizon. Phytochem. Rev. 2017, 16, 271–293. [Google Scholar] [CrossRef]
- Gupta, S.; Chaturvedi, P.; Kulkarni, M.G.; Staden, J.V. A critical review on exploiting the pharmaceutical potential of plant endophytic fungi. Biotechnol. Adv. 2020, 39, 107462. [Google Scholar] [CrossRef]
- Brakhage, A.A. Regulation of fungal secondary metabolism. Nat. Rev. Microbiol. 2013, 11, 21–32. [Google Scholar] [CrossRef]
- Nielsen, J.C.; Grijseels, S.; Prigent, S.; Ji, B.; Dainat, J.; Nielsen, K.F.; Frisvad, J.C.; Workman, M.; Nielsen, J. Global analysis of biosynthetic gene clusters reveals vast potential of secondary metabolite production in Penicillium species. Nat. Microbiol. 2017, 2, 17044. [Google Scholar] [CrossRef]
- Knowles, S.L.; Raja, H.A.; Roberts, C.D.; Oberlies, N.H. Fungal-fungal co-culture: A primer for generating chemical diversity. Nat. Prod. Rep. 2022, 39, 1557. [Google Scholar] [CrossRef]
- Liu, B.; Wang, Y.X.; Chen, N.; Li, C.X.; Zhao, J.T.; Li, T. Advances in chemical epigenetic modification methods in the study of fungal secondary metabolites. Mini-Rev. Org Chem. 2024, 21, 1–10. [Google Scholar] [CrossRef]
- Qiao, Y.M.; Yu, R.L.; Zhu, P. Advances in targeting and heterologous expression of genes involved in the synthesis of fungal secondary metabolites. RSC Adv. 2019, 9, 35124. [Google Scholar] [CrossRef]
- Hu, Y.W.; Zhao, X.Y.; Song, Y.; Jiang, J.H.; Long, T.; Cong, M.J.; Miao, Y.H.; Liu, Y.H.; Yang, Z.Y.; Zhu, Y.G.; et al. Anti-inflammatory and neuroprotective α-pyrones from a marine derived strain of the fungus Arthrinium arundinis and their heterologous expression. J. Nat. Prod. 2024, 87, 1975–1982. [Google Scholar] [CrossRef]
- Lu, Y.B.; Li, Y.P.; Dou, M.; Liu, D.; Lin, W.H.; Fan, A.L. Discovery of a hybrid molecule with phytotoxic activity by genome mining, heterologous expression, and OSMAC strategy. J. Agric. Food Chem. 2024, 72, 18520–18527. [Google Scholar] [CrossRef]
- Helaly, S.E.; Thongbai, B.; Stadler, M. Diversity of biologically active secondary metabolites from endophytic and saprotrophic fungi of the ascomycete order Xylariales. Nat. Prod. Rep. 2018, 35, 992–1014. [Google Scholar] [CrossRef]
- Qin, X.D.; Shao, H.J.; Dong, Z.J.; Liu, J.K. Six new induced sesquiterpenes from the cultures of ascomycete Daldinia Concentrica. J. Antibiot. 2008, 61, 556–562. [Google Scholar] [CrossRef]
- Zhou, X.; Yang, C.L.; Meng, Q.F.; Liu, L.; Fu, S.B. A new alkanol from the endolichenic fungus Daldinia childiae. J. Chin. Chem. Soc. 2021, 68, 1–4. [Google Scholar] [CrossRef]
- Gong, D.W.; Xie, B.P.; Sun, Y.J.; Cheng, Y.Y.; Tian, X.F.; Zhou, Z.Z.; Tian, L.W. Daldiconoids A-G: 3,4-secolanostane triterpenoids from the fruiting bodies of Daldinia concentrica and their anti-inflammatory activity. Phytochemistry 2024, 225, 114201. [Google Scholar] [CrossRef]
- Stadler, M.; Baumgartner, M.; Grothe, T.; Muhlbauer, A.; Seip, S.; Wollweber, H. Concentricol, a taxonomically significant triterpenoid from Daldinia concentrica. Phytochemistry 2001, 56, 787–793. [Google Scholar] [CrossRef]
- Quang, D.N.; Hashimoto, T.; Tanaka, M.; Baumgartner, M.; Stadler, M.; Asakawa, Y. Concentriols b, c and d, three squalene-type triterpenoids from the ascomycete Daldinia concentrica. Phytochemistry 2002, 61, 345–353. [Google Scholar] [CrossRef]
- Buchanan, M.S.; Hashimoto, T.; Asakawa, Y. Five 10-phenyl-[11]-cytochalasans from a Dalinia fungal species. Phytochemistry 1995, 40, 135–140. [Google Scholar] [CrossRef]
- Buchanan, M.S.; Hashimoto, T.; Asakawa, Y. Cytochalasins from a Daldinia sp. fungus. Phytochemistry 1996, 41, 821–828. [Google Scholar] [CrossRef]
- Buchanan, M.S.; Hashimoto, T.; Takaoka, S.; Kan, Y.; Asakawa, Y. A 10-phenyl-[11]-cytochalasan from a species of Daldinia. Phytochemistry 1996, 42, 173–176. [Google Scholar] [CrossRef]
- Trung, H.V.; Kuo, P.C.; Tuan, N.N.; Ngan, N.T.; Trung, N.Q.; Thanh, N.T.; Hai, H.V.; Phuong, D.L.; Giang, B.L.; Li, Y.C.; et al. Characterization of cytochalasins and steroids from the ascomycete Daldinia concentrica and their cytotoxicity. Nat. Prod. Commun. 2009, 14, 1–5. [Google Scholar] [CrossRef]
- Yang, L.J.; Liao, H.X.; Bai, M.; Huang, G.L.; Luo, Y.P.; Niu, Y.Y.; Zheng, C.J.; Wang, C.Y. One new cytochalasin metabolite isolated from a mangrove-derived fungus Daldinia eschscholtzii HJ001. Nat. Prod. Res. 2018, 32, 208–213. [Google Scholar] [CrossRef]
- Qing, X.D.; Dong, Z.J.; Liu, J.K. Two new compounds from the ascomycete Daldinia concentrica. Helv. Chim. Acta 2006, 89, 450–455. [Google Scholar]
- Quang, D.N.; Hashimoto, T.; Tanaka, M.; Baumgartner, M.; Stadler, M.; Asakawa, Y. Chemical constituents of the ascomycete Daldinia concentrica. J. Nat. Prod. 2002, 65, 1869–1874. [Google Scholar] [CrossRef]
- Xu, Z.Y.; Feng, T.; Wen, Z.C.; Li, Q.; Chen, B.T.; Liu, P.H.; Xu, J. New Naphthalene derivatives from the mangrove endophytic fungus Daldinia eschscholzii MCZ-18. Mar. Drugs. 2024, 22, 242. [Google Scholar] [CrossRef]
- Lin, L.P.; Wu, M.; Jiang, N.; Wang, W.; Tan, R.X. Carbon-nitrogen bond formation to construct novel polyketide-indole hybrids from the indole-3-carbinol exposed culture of Daldinia Eschscholzii. Synth. Syst. Biotechnol. 2022, 7, 750–755. [Google Scholar] [CrossRef]
- Lin, L.P.; Jiang, N.; Wu, H.M.; Mei, Y.N.; Yang, J.; Tan, R.X. Cytotoxic and antibacterial polyketide-indole hybrids synthesized from indole-3-carbinol by Daldinia Eschscholzii. Acta Pharm. Sin. B. 2019, 9, 369–380. [Google Scholar] [CrossRef]
- Lin, L.P.; Tan, R.X. Bioactive alkaloids from indole-3-carbinol exposed culture of Daldinia eschscholzii. Chin. J. Chem. 2018, 36, 749–753. [Google Scholar] [CrossRef]
- Kamauchi, H.; Shiraishi, Y.; Kojima, A.; Kawazoe, N.; Kinoshita, K.; Koyama, K. Isoindolinones, phthalides, and a naphthoquinone from the fruiting body of Daldinia concentrica. J. Nat. Prod. 2018, 81, 1290–1294. [Google Scholar] [CrossRef]
- Ki, D.W.; Kim, S.E.; Kim, J.Y.; Song, J.G.; Hwang, B.S.; Lee, I.K.; Yun, B.S. Daldinans D-G, new isoindolinone antioxidants isolated from the ascomycete Daldinia concentrica. J. Nat. Med. 2022, 76, 476–481. [Google Scholar] [CrossRef]
- Kamauchi, H.; Goto, M.; Sugita, Y. Synthesis of daldinans and dynamic stereochemistry of their atropisomers. J. Org. Chem. 2024, 89, 8960–8969. [Google Scholar] [CrossRef]
- Zhao, Z.Z.; Chen, H.P.; Huang, Y.; Zhang, S.B.; Li, Z.H.; Feng, T.; Liu, J.K. Bioactive polyketides and 8,14-seco-ergosterol from fruiting bodies of the ascomycete Daldinia childiae. Phytochemistry 2017, 142, 68–75. [Google Scholar] [CrossRef]
- Lee, I.K.; Kim, S.E.; Yeom, J.H.; Ki, D.W.; Lee, M.S.; Song, J.G.; Kim, Y.S.; Seok, S.J.; Yun, B.S. Daldinan A, a novel isoindolinone antioxidant from the ascomycete Daldinia concentrica. J. Antibiot. 2012, 65, 95–97. [Google Scholar] [CrossRef]
- Hu, Z.X.; Xue, Y.B.; Bi, X.B.; Zhang, J.W.; Luo, Z.W.; Li, X.N.; Yao, G.M.; Wang, J.P.; Zhang, Y.H. Five New secondary metabolites produced by a marine-associated fungus Daldinia eschscholzii. Mar. Drugs. 2014, 12, 5563–5575. [Google Scholar] [CrossRef]
- Lee, S.; Park, I.G.; Choi, J.W.; Son, J.Y.; Lee, J.W.; Hur, J.S.; Kim, Y.; Nam, S.J.; Kang, H.S.; Deyrup, S.T.; et al. Daldipyrenones A-C: Caged [6,6,6,6,6] polyketides derived from an endolichenic fungus Daldinia pyrenaica 047188. Org. Lett. 2023, 25, 6725–6729. [Google Scholar] [CrossRef]
- Wutthiwong, N.; Suthiphasilp, V.; Pintatum, A.; Suwannarach, N.; Kumla, J.; Lomyong, S.; Maneerat, T.; Charoensup, R.; Cheenpracha, S.; Limtharakul, T.; et al. Daldiniaeschsone A, a rare tricyclic polyketide having a chromone unit fused to a δ-lactone and its symmetrical biphenyl dimer, daldiniaeschsone B, from an endophytic fungus Daldinia eschscholtzii SDBR-CMUNKC745. J. Fungi 2021, 7, 358. [Google Scholar] [CrossRef]
- Wang, G.; Fan, J.Y.; Zhang, W.J.; Hua, C.P.; Chen, C.J.; Yan, W.; Ge, H.M.; Jiao, R.H.; Tan, R.X. Polyketides from mantis-associated fungus Daldinia eschscholzii IFB-TL01. Chem. Biodivers. 2015, 12, 1349–1355. [Google Scholar] [CrossRef]
- Liao, H.X.; Shao, T.M.; Mei, R.Q.; Huang, G.L.; Zhou, X.M.; Zheng, C.J.; Wang, C.Y. Bioactive secondary metabolites from the culture of the mangrove-derived fungus Daldinia eschscholtzii HJ004. Mar. Drugs. 2019, 17, 710. [Google Scholar] [CrossRef]
- Lu, S.M.; Liao, C.J.; Xu, Y.; Gui, T.Y.; Sui, H.L.; Zhou, M. Two new ketene derivatives from the endophytic fungus Daldinia eschscholtzii J11. Phytochem. Lett. 2023, 58, 81–85. [Google Scholar] [CrossRef]
- Wang, B.Y.; Yang, Y.B.; Yang, X.Q.; Zhu, C.H.; Yang, S.; Xu, T.T.; Wang, X.Y.; Tan, N.H.; Zhou, H.; Ding, Z.T. Inducing secondary metabolite production from Daldinia eschscholzii JC-15 by red ginseng medium. Nat. Prod. Lett. 2020, 34, 3101–3107. [Google Scholar] [CrossRef]
- Sibero, M.T.; Zhou, T.; Igarashi, Y.; Radjasa, O.K.; Sabdono, A.; Trianto, A.; Bachtiarini, T.U.; Bahry, M.S. Chromanone-type compounds from marine sponge-derived Daldinia eschscholtzii KJMT FP 4.1. J. Appl. Pharm. Sci. 2020, 10, 001–007. [Google Scholar]
- Luo, Y.; Qiu, L.; Deng, Y.; Yuan, X.H.; Gao, P. A new chromone and a new aliphatic ester isolated from Daldinia eschscholtzii. J. Asian Nat. Prod. Res. 2018, 20, 883–888. [Google Scholar] [CrossRef]
- Liao, H.X.; Zheng, C.J.; Huang, G.L.; Mei, R.Q.; Nong, X.H.; Shao, T.M.; Chen, G.Y.; Wang, C.Y. Bioactive polyketide derivatives from the mangrove-derived fungus Daldinia eschscholtzii HJ004. J. Nat. Prod. 2019, 82, 2211–2219. [Google Scholar] [CrossRef]
- Zhang, D.W.; Gu, G.W.; Zhang, B.Y.; Wang, Y.J.; Bai, J.L.; Fang, Y.A.; Zhang, T.; Dai, S.J.; Cen, S.; Yu, L.Y. New phenol and chromone derivatives from the endolichenic fungus Daldinia species and their antiviral activities. RSC Adv. 2021, 11, 22489–22494. [Google Scholar] [CrossRef]
- Wang, B.; Zeng, W.N.; Li, G.Y.; Xiao, M.; Wei, F.F.; Luo, Y.P.; Niu, Z.G.; Huang, G.L.; Zheng, C.J. Three new secondary metabolites from the mangrove-derived fungus Daldinia eschscholtzii HJ004. Chin. J. Org. Chem. 2023, 1, 332–337. [Google Scholar] [CrossRef]
- Liu, H.X.; Tan, H.B.; Li, S.N.; Chen, Y.C.; Li, H.H.; Zhang, W.M. Two new metabolites from Daldinia eschscholtzii, an endophytic fungus derived from Pogostemon Cablin. J. Asian Nat. Prod. Res. 2019, 21, 150–156. [Google Scholar] [CrossRef]
- Wang, G.S.; Yin, Z.H.; Wang, S.Y.; Yuan, Y.L.; Chen, Y.; Kang, W.Y. Diversified polyketides with Anti-inflammatory activities from mangrove endophytic fungus Daldinia eschscholtzii KBJYZ-1. Front. Microbiol. 2022, 13, 900227. [Google Scholar] [CrossRef]
- Chen, J.X.; Yang, X.Q.; Wang, X.Y.; Han, H.L.; Cai, Z.J.; Xu, H.; Yang, Y.B.; Ding, Z.T. Antifeedant, antifungal cryptic polyketides with six structural frameworks from tea endophyte Daldinia eschscholtzii propelled by the antagonistic coculture with phytopathogen colletotrichum pseudomajus and different culture methods. J. Agric. Food Chem. 2024, 72, 378–389. [Google Scholar] [CrossRef]
- Barnes, E.C.; Jumpathong, J.; Lumyong, S.; Voigt, K.; Hertweck, C. Daldionin, an unprecedented binaphthyl derivative, and diverse polyketide congeners from a fungal orchid endophyte. Chem. Eur. J. 2016, 22, 4551–4555. [Google Scholar] [CrossRef]
- Tarman, K.; Palm, G.J.; Porzel, A.; Merzweiler, K.; Arnold, N.; Wessjohann, L.A.; Unterseher, M.; Lindequist, U. Helicascolide C, a new lactone from an indonesian marine algicolous strain of Daldinia eschscholzii (Xylariaceae, ascomycota). Phytochem. Lett. 2012, 5, 83–86. [Google Scholar] [CrossRef]
- Qin, X.D.; Dong, Z.J.; Liu, J.K. Concentricolide, an anti-HIV agent from the ascomycete Daldinia concentrica. Helvetica Chimica Acta. 2006, 89, 127–133. [Google Scholar] [CrossRef]
- Shao, H.J.; Qin, X.D.; Dong, Z.J.; Zhang, H.B.; Liu, J.K. Induced daldinin A, B, C with a new skeleton from cultures of the ascomycete Daldinia Concentrica. J. Antibiot. 2008, 61, 115–119. [Google Scholar] [CrossRef]
- Du, L.; King, J.B.; Cichewicz, R.H. Chlorinated polyketide obtained from a Daldinia sp. treated with the epigenetic modifier suberoylanilide hydroxamic acid. J. Nat. Prod. 2014, 77, 2454–2458. [Google Scholar] [CrossRef]
- Qin, X.D.; Liu, J.K. Three new homologous 3-alkyl-1,4-benzoquinones from the fruiting bodies of Daldinia Concentrica. Helv. Chim. Acta. 2004, 87, 2022–2024. [Google Scholar] [CrossRef]
- Gu, G.W.; Cai, G.W.; Wang, Y.J.; Li, L.; Bai, J.L.; Zhang, T.; Cen, S.; Zhang, D.W.; Yu, L.Y. Daldispones A and B, two new cyclopentenones from Daldinia sp. CPCC 400770. J. Antibiot. 2021, 74, 215–218. [Google Scholar] [CrossRef]
- Zhou, Z.Z.; Zhu, H.J.; Yang, C.L.; Liu, Y.J.; Jiang, N.; Xiao, Y.S.; Shi, L.Y.; Jiao, R.H.; Ge, H.M.; Tan, R.X. Dalestones A and B, two anti-inflammatory cyclopentenones from Daldinia eschscholzii with an edited strong promoter for the global regulator LaeA-like gene. Chin. J. Nat. Med. 2019, 17, 387–393. [Google Scholar] [CrossRef]
- Kim, J.; Ko, H.; Hur, J.S.; An, S.; Lee, J.W.; Seyrup, S.T.; Noh, M.; Shim, S.H. Discovery of pan-peroxisome proliferator-activated receptor modulators from an endolichenic fungus, Daldinia childiae. J. Nat. Prod. 2022, 85, 2804–2816. [Google Scholar] [CrossRef]
- Kim, J.; He, M.T.; Hur, J.S.; Lee, J.W.; Kang, K.B.; Kang, K.S.; Shim, S.H. Discovery of naphthol tetramers from endolichenic fungus Daldinia childiae 047219 based on MS/MS molecular networking. J. Nat. Prod. 2023, 86, 2031–2038. [Google Scholar] [CrossRef]
- Zhang, A.H.; Jiang, N.; Wang, X.Q.; Tan, R.X. Galewone, an anti-fibrotic polyketide from Daldinia eschscholzii with an undescribed carbon skeleton. Sci. Rep. 2019, 9, 14316. [Google Scholar] [CrossRef]
- Zhang, A.H.; Liu, W.; Jiang, N.; Xu, Q.; Tan, R.X. Spirodalesol, an NLRP3 inflammasome activation inhibitor. Org. Lett. 2016, 18, 6496–6499. [Google Scholar] [CrossRef] [PubMed]
- Zhang, A.H.; Tan, R.; Jiang, N.; Yusupu, K.; Wang, G.; Wang, X.L.; Tan, R.X. Selesconol, a fungal polyketide that induces stem cell differentiation. Org. Lett. 2016, 18, 5488–5491. [Google Scholar] [CrossRef] [PubMed]
- Zhang, Y.L.; Ge, H.M.; Zhao, W.; Dong, H.; Xu, Q.; Li, S.H.; Li, J.; Zhang, J.; Song, Y.C.; Tan, R.X. Unprecedented immunosuppressive polyketides from Daldinia eschscholzii, a mantis-associated fungus. Angew. Chem. Int. Ed. 2008, 47, 5823–5826. [Google Scholar] [CrossRef] [PubMed]
- Nadeau, A.K.; Sorensen, J.L. Polyketides produced by Daldinia loculata cultured from northern manitoba. Tetrahedron Lett. 2011, 52, 1697–1699. [Google Scholar] [CrossRef]
- Lin, S.; Yan, S.; Liu, Y.; Zhang, X.; Cao, F.; He, Y.; Li, F.L.; Liu, J.J.; Wang, J.P.; Hu, Z.X.; et al. New secondary metabolites with immunosuppressive and BChE inhibitory activities from an endophytic fungus Daldinia sp. TJ403-LS1. Bioorg. Chem. 2021, 114, 105091. [Google Scholar] [CrossRef]
- Feng, T.; Li, Z.H.; Yin, X.; Dong, Z.J.; Wang, G.Q.; Li, X.Y.; Li, Y.; Liu, J.K. New benzene derivatives from cultures of ascomycete Daldinia concentrica. Nat. Prod. Bioprospect. 2013, 3, 150–153. [Google Scholar] [CrossRef][Green Version]
- Kongyen, W.; Rukachaisirikul, V.; Phongpaichit, S.; Sakayaroj, J. A new hydronaphthalenone from the mangrove-derived Daldinia eschscholtzii PSU-STD57. Nat. Prod. Res. 2015, 29, 1995–1999. [Google Scholar] [CrossRef]
Disclaimer/Publisher’s Note: The statements, opinions and data contained in all publications are solely those of the individual author(s) and contributor(s) and not of MDPI and/or the editor(s). MDPI and/or the editor(s) disclaim responsibility for any injury to people or property resulting from any ideas, methods, instructions or products referred to in the content. |
© 2024 by the authors. Licensee MDPI, Basel, Switzerland. This article is an open access article distributed under the terms and conditions of the Creative Commons Attribution (CC BY) license (https://creativecommons.org/licenses/by/4.0/).